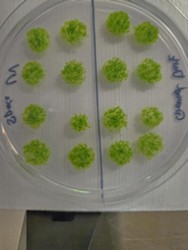

Goroldioaren habitata espazioraino heltzen da
Egoera bortitzetan bizirauten duten izaki bizidunetan pentsatzen dugunean, seguruenik goroldioa ez da izango burura datorkigun lehenengoa. Hala ere, goroldioa —duela 450 milioi urte lur-inguruneak erdietsi zituen lehen organismo biziduna— aurkitu dezakegu bai Himalaiako tontorretan bai Indonesiako sumendi aktiboen laba-zelaietan. Hori dela eta, orain, zientzialariek goroldio-esporak bidali dituzte espaziora, etorkizunean gizakiok beste planeta bat kolonizatzeko gai izango garen ikertzeko lehen urrats gisa.
Lurreko ekosistemek aldaketa bortitzak jasaten dituzte geroz eta maiztasun handiagoz. Baldintza abiotikoak, hala nola tenperatura, hezetasuna, eguzki-argia edo substratuaren pH-a aldatzeak, efektu zuzena du ekosistemetako bizitzan. Azken hamarkadetan, klima-aldaketaren ondorioz azkartu egin dira baldintza-aldaketa horiek, eta biodibertsitatearen galera eta desertifikazioa arazo errealak bihurtu dira, mundu osoan aurreikusten zena baino lehen.
Egoera horren aurrean, zientzialariek izaki bizidunen biziraupena bermatzeko esplorazioa espaziora heldu da azken hamarkadetan. Hala ere, izaki bizidunak ilargian edo Marten bizi ahal izateko, ezinbestekoa da ondo ulertzea organismo lurtarrek muturreko baldintzetan dituzten erresilientzia-mekanismoak. Izan ere, Lurreko izaki bizidunen eboluzioaren historian badira hainbat eredu, non organismoak baldintza abiotiko guztiz ezberdinetara moldatu diren; hala nola, izaki bizidunak ur-inguruneetatik lur-inguruneetara igarotzea lortu zuten. Iragate horretan, organismo bizidunek lur-inguruneetako baldintza bortitzei aurre egiteko erresilientzia-mekanismoak garatu behar izan zituzten.
 1. irudia: espaziora bidali ziren goroldio-esporak gordetzen dituen esporofito heldua. (Argazkia: Tomomichi Fujita)
1. irudia: espaziora bidali ziren goroldio-esporak gordetzen dituen esporofito heldua. (Argazkia: Tomomichi Fujita)Briofitoak izan ziren lur lehorra kolonizatu zuten lehen organismo biziak, eta geroztik ez dira desagertu. Briofitoen artean, goroldioak ditugu ezagunenak. Gaur egun, izaki bizidun horiek muturreko inguruneetan aurkitu ditzakegu; hala nola, Himalaiako tontorretan, Kaliforniako desertuko hareetan, Antartikako tundran edo Indonesiako sumendi aktiboetako laba-zelaietan. Orain, Japoniako Hokkaido Unibertsitateko ikertalde batek goroldio-esporofitoak (esporak dituzten landareen ugalketa-egiturak) bidali ditu orain arteko ingurune muturrekoenera: espaziora.
Bederatzi hilez espazioko elementuekin kontaktuaniScience aldizkarian argitaratutako artikuluak honako hau ikertzen du: goroldioek baldintza bortitzen aurrean dituzten erresilientzia-mekanismoak. Horretarako, ikertzaileek bederatzi hilez nazioarteko espazio-estazioaren kanpoko eremuan utzi zituzten landare-esporak. «Izaki bizidun gehienek, gizakiek barne, ezin dute espazioaren hutsunean laburki ere biziraun», dio artikuluaren egile nagusia den Tomomichi Fujitak. «Hala ere, goroldio-esporek bizitasuna gorde zuten bederatzi hilabetez espazioko elementuekin zuzenean kontaktuan egon ondoren. Horrek argi eta garbi erakusten du lur-inguruneetara egokitutako bizitzak badituela, zelula-mailan, espazioko baldintzak jasateko mekanismo intrintsekoak».
2022ko martxoan, ikertzaileek ehunka goroldio-espora bidali zituzten nazioarteko espazio-estaziora. Iristean, astronautek espazio-estazioaren kanpoaldean itsatsi zituzten laginak, eta, guztira, 283 egunez egon ziren espazioan inongo babesik gabe. Goroldioak 2023ko urtarrilean itzuli ziren Lurrera SpaceX CRS-16 espazio-ontzian; ondoren, Lurreko atmosferarekin kontaktua izatea saihestuz, laborategira eraman zituzten berriro goroldio-espora horiek, ikertzeko.
Physcomitrium patens: espazioko goroldioaJaponiako Hokkaido Unibertsitateko Fujita irakaslea, landareen bilakaera eta eboluzioa aztertzen ari zela, harritu egin zen goroldioak Lurreko inguru bortitzenak konkistatzeko duen gaitasunarekin: «Neure buruari galdezka hasi nintzaion: landare txiki baina indartsu honek espazioan ere biziraun al dezake?». Galderari erantzuna bilatzeko asmoz, irakasleak zuzentzen duen ikertaldeak espazioko baldintzapean jarri zuen Physcomitrium patens.
2. irudia: espazioan egon diren ernamuindutako goroldio-esporak. (Argazkia: Dr. Chang-hyun Maeng eta Maika Kobayashi)
2. irudia: espazioan egon diren ernamuindutako goroldio-esporak. (Argazkia: Dr. Chang-hyun Maeng eta Maika Kobayashi)Horretarako, hiru goroldio-egitura (gazte-goroldioa, hazkuntza-zelulak edo zelula ama espezializatuak, eta goroldio-esporak) aztertu zituzten tenperatura bortitz, ultrabioleta-erradiazio eta huts baldintzetan. Lurreko izaki bizidunek estres abiotiko ugariri aurre egin behar dioten arren, «aurreikusi genuen espazioko baldintzek berez Lurreko edozein estresek baino askoz kalte handiagoa eragingo luketela”, adierazi du Fujitak.
Ikertzaileek aurkitu zuten espazioko baldintza bortitz guztien artean ultrabioleta-erradiazioak zailtzen zuela gehien goroldioaren biziraupena. Goroldio gazteek eta hazkuntza-zelulek biziraupen-tasa txikiak izan zituzten ultrabioleta-erradiazioaren eta tenperatura bortitzen aurrean. Ez zen horrela izan goroldio-esporen kasuan; – 196 ºC-ren eta 55 ºC-ren eraginpean biziraun eta garatu egin ziren.
Babes-hesian oinarritutako erresilientziaLaborategiko emaitzak ikusita, irrikaz itxaron zituen ikertaldeak espaziora bidalitako laginak; jaso zituztenean, lortutako ondorioak berretsi zituzten. Izan ere, bidalitako esporen % 80 bizirik itzuli zen espazio-bidaiatik, eta horietatik soilik % 11 ez ziren garatu laborategian. Ikertaldeak goroldio-esporen klorofila-mailak ere ikertu zituen, eta maila normalak aurkitu zituen mota guztietarako, a klorofilaren kasuan izan ezik; azken kasu horretan % 20ko murrizketa izan zuen. Konposatu hori bereziki sentikorra da argi ikusgaiko aldaketekiko; aldaketa horrek, ordea, ez zirudien goroldio-esporen osasunari eragin zionik.
Ikertzaileen ustez, goroldio-esporak estaltzen duen egiturak babes-hesi gisa jokatzen du, erradiazioa xurgatuz eta barne-espora fisikoki zein kimikoki isolatuz. Litekeena da eboluzio-egokitzapen bat izatea; horri esker, briofitak (goroldioak kide diren landare taldea) ur-inguruneetatik lur-inguruneetara igaro ahal izan ziren duela 500 milioi urte, eta, ordutik, biziraun egin dute hainbat desagertze masiboren aurrean.
Erreferentzia bibliografikoa:Maeng, Chang-hyun; Hiwatashi, Yuji; Nakamura, Keita; Matsuda, Osamu; Mita, Hajime; Tomita-Yokotani, Kaori; Yokobori, Shin-ichi; Yamagishi, Akihiko; Kume, Atsushi; Fujita, Tomomichi (2025). Extreme environmental tolerance and space survivability of the moss, Physcomitrium patens. iScience, 28, 12. DOI: 10.1016/j.isci.2025.113827
Egileaz:Oxel Urra Elektrokimikan doktorea da, zientziaren eta artea uztartzen duten proiektuetan aditua, egun zientzia-komunikatzailea da.
The post Goroldioaren habitata espazioraino heltzen da appeared first on Zientzia Kaiera.
Una nueva estimación del grosor de la corteza de hielo de Europa
Si en el artículo Por qué los satélites de Júpiter son como son hablábamos de por qué los satélites jovianos pueden ser tan radicalmente diferentes, hoy nos vamos a centrar en Europa, un cuerpo fascinante desde el punto de vista de la geología y la astrobiología.
No es casualidad este interés. Cuando miramos a este satélite lo que vemos es un cuerpo que podría contener un océano de agua líquida -subterráneo- con un volumen de alrededor del doble del de los océanos terrestres. Eso sí, encerrado bajo una corteza de hielo bombardeada por la radiación de Júpiter.
Pero, ¿hasta que profundidad llega esa corteza? A lo largo de las últimas décadas, ha habido muchos cálculos basados en distintos datos indirectos y las estimaciones han ido desde unos pocos kilómetros hasta más de treinta. Y responder a esta cuestión es importantísimo, porque el espesor nos indica si el océano interactúa con la superficie permitiendo intercambio de nutrientes y otros elementos necesarios para la vida.
 Figura 1. Aquí podemos ver una de las imágenes más recientes -de alta resolución- de Europa, en este caso tomada por la sonda Juno en septiembre de 2022. Lo más llamativo es la gran cantidad de sistemas de fracturas que cruzan la práctica totalidad del satélite y el escaso número de cráteres de impacto, atestiguando la juventud de su superficie. Imagen cortesía de NASA/JPL-Caltech/SwRI/MSSS Image /Kevin M. Gill CC BY 3.0.
Figura 1. Aquí podemos ver una de las imágenes más recientes -de alta resolución- de Europa, en este caso tomada por la sonda Juno en septiembre de 2022. Lo más llamativo es la gran cantidad de sistemas de fracturas que cruzan la práctica totalidad del satélite y el escaso número de cráteres de impacto, atestiguando la juventud de su superficie. Imagen cortesía de NASA/JPL-Caltech/SwRI/MSSS Image /Kevin M. Gill CC BY 3.0.La historia de hoy comienza con la llegada de la sonda Juno al sistema joviano en 2016. La misión, en principio, no tenía previsto estudiar las lunas heladas con tal nivel de detalle, pero uno de sus instrumentos -el radiómetro de microondas (MWR)-, diseñado para estudiar la atmósfera de Júpiter, fue también usado para intentar recabar datos sobre la corteza de Europa durante un sobrevuelo cercano, obteniendo unos datos muy interesantes.
Y bueno, ¿qué es lo que ha “visto” exactamente este instrumento? Para simplificar, lo primero que ha podido estudiar es la temperatura del hielo en profundidad. Si pensamos en las temperaturas que esperamos, la superficie del océano estaría a unos 273ºK, mientras que la superficie del hielo de la corteza estaría a tan solo 100ºK. Por lo tanto, la temperatura del hielo tendría que aumentar conforme vamos descendiendo hacia las profundidades de la corteza. Si este hielo estuviese formado por un bloque sólido y con las mismas propiedades en todas partes, la Juno habría visto una subida gradual de la temperatura de arriba hacia abajo.
Pero eso no es lo que vieron, sino que encontraron una estructura mucho más compleja algo que, por otro lado, no era descartable. Para poder interpretar los datos obtenidos, los científicos han tenido que usar un sofisticado modelo de transferencia radiativa -un modelo matemático que estudia transferencia de energía y su interacción con la materia que atraviesa- para transformar las señales de microondas en una estructura física.
La consecuencia es una nueva estimación del grosor de la corteza de hielo de Europa. Suponiendo que esté hecha de agua pura, los datos obtenidos son consistentes con una corteza de hielo de 29±10 kilómetros de espesor. Estas medidas se sitúan en el margen superior de las estimaciones más aceptadas por la comunidad científica.
Pero ojo, aquí hay otro detalle importantísimo: si debajo de esta capa existiese otra de hielo más cálido y convectivo -algo que no es descartable- habría que añadirla a esta estimación, por lo que probablemente estemos hablando de que esta sería el límite inferior de la horquilla de posibilidades.
 Figura 2. Una de las esperanzas para favorecer la hipótesis de un océano habitable es que estos sistemas de fracturas, crestas y surcos continuasen su estructura hasta partes mucho más bajas de la corteza de Europa… ¿serán finalmente un “arañazo” en la superficie? Imagen cortesía de NASA/JPL.
Figura 2. Una de las esperanzas para favorecer la hipótesis de un océano habitable es que estos sistemas de fracturas, crestas y surcos continuasen su estructura hasta partes mucho más bajas de la corteza de Europa… ¿serán finalmente un “arañazo” en la superficie? Imagen cortesía de NASA/JPL.Este hallazgo tiene grandes implicaciones desde el punto de vista de la geología. El flujo de calor que implica una corteza de este espesor coincide con los modelos de calentamiento por mareas, el origen de una parte importante de la energía interna del satélite, encargada de mantener el océano líquido y alimentar los procesos geológicos.
Y hay un detalle más: el instrumento MWR ha permitido a los científicos estudiar la textura interna de la capa de hielo. Y a partir de estos datos han observado zonas donde el hielo está bastante alterado, lo que en otros momentos ha llevado a especular sobre la posible existencia de lagos subterráneos, bolsas de salmuera o sistemas de grandes fisuras.
Esto se ha visto a partir de la aparición de elementos “dispersores”, discontinuidades en el hielo como fisuras, huecos o poros. Analizando como las distintas frecuencias dispersaban la radiación, el equipo pudo deducir que estos defectos en la capa de hielo son relativamente pequeños, con un tamaño característico de apenas unos centímetros.
Además, estos no estarían distribuidos por la corteza de una manera homogénea, sino que estarían concentrados en la parte superior, hasta unos pocos cientos de metros de profundidad. La fracción del volumen de hielo que ocupan es poca, y va haciéndose menor conforme profundizamos.
Este último detalle, que nos puede parecer un poco técnico, podría tener fuertes consecuencias de cara a la habitabilidad de Europa. Para que este cuerpo tuviese la posibilidad de albergar vida, es muy probable que su océano subterráneo necesitara un suministro de oxidantes y nutrientes generados en su superficie por el efecto de la radiación. Si la capa de hielo está plagada de grandes sistemas de fisuras, fallas o sistemas de poros interconectados, estos materiales podrían llegar hasta el océano.
Sin embargo, los hallazgos de este estudio sugieren que no es el caso. El escaso volumen, el pequeño tamaño y la poca profundidad a la que aparecen, indican que es poco probable que las fracturas que se ven en la superficie sean capaces por si solas de generar un intercambio de elementos y compuestos con el océano, mostrando la imagen de una Europa cuyo exterior e interior están desconectados y, que las formas geológicas que vemos y que nos indican cierta actividad, podrían en realidad encontrarse sobre kilómetros de hielo sólido y aislante.
 Figura 3. ¿Podrían ser los cráteres de impacto, en el caso de que la corteza fuese tan gruesa, una forma de conectar el interior de Europa con el exterior? Aquí en esta imagen podemos ver algunas de las grandes estructuras de impacto que hay sobre su superficie. Una manera en la que pudiesen servir estas para permitir el intercambio sería generando sistemas de fracturas -o propagando los existentes- hacia el interior, junto con la fusión del hielo provocada por el impacto. Imagen cortesía de NASA/JPL/DLR.
Figura 3. ¿Podrían ser los cráteres de impacto, en el caso de que la corteza fuese tan gruesa, una forma de conectar el interior de Europa con el exterior? Aquí en esta imagen podemos ver algunas de las grandes estructuras de impacto que hay sobre su superficie. Una manera en la que pudiesen servir estas para permitir el intercambio sería generando sistemas de fracturas -o propagando los existentes- hacia el interior, junto con la fusión del hielo provocada por el impacto. Imagen cortesía de NASA/JPL/DLR.Los cálculos están basados en la asunción de que el hielo de la corteza es de agua pura, pero la presencia de sales en este hielo podría cambiar el ajuste del modelo. De hecho, si asumimos un hielo con unos 15 mg de sal por kilo de hielo -parecido a la composición del hielo de los mares terrestres- la capa de hielo se reduciría 5 kilómetros, aunque seguiría dentro del margen de incertidumbre de los 10 kilómetros que han obtenido los científicos, por lo que la corteza seguiría siendo gruesa.
Estos hallazgos representan un avance francamente importante. Hemos pasado de ver los grandes sistemas de fracturas de Europa en una imagen a conocer el gradiente de temperaturas de toda la capa de hielo. Y lo que surge es una capa estable, gruesa y que aísla al océano del vacío del espacio. Si bien esto confirma que el océano está bien protegido, también sugiere que está más aislado de lo que esperaban los modelos más optimistas.
La vía para que sea un mundo habitable -el intercambio de materia y energía desde fuera hacia adentro- parece ser, a la vista de estos datos, complicado al no observarse una continuidad de los sistemas de fracturas desde el exterior al interior. Este hecho no elimina de un plumazo la posibilidad de que sea un mundo habitable, ya que podría haber otros mecanismos no detectados en este sobrevuelo, como regiones que puedan estar geológicamente activas o el papel de los impactos en facilitar ese intercambio.
Habrá que esperar a las futuras misiones JUICE y Europa Clipper que nos podrán aportar nuevos y mejores datos -al fin y al cabo, Juno no estaba preparada para esto- y confirmar o refinar estas medidas. Y, por supuesto, a abrir nuevas preguntas e interrogantes.
Referencias:
Levin, S. M., Zhang, Z., Bolton, S. J., Brown, S., Ermakov, A. I., Feng, J., Hand, K., Misra, S., Siegler, M., Stevenson, D., McKinnon, W., & Akiba, R. (2025) Europa’s ice thickness and subsurface structure characterized by the Juno microwave radiometer Nature Astronomy doi: 10.1038/s41550-025-02718-0
Sobre el autor: Nahúm Méndez Chazarra es geólogo planetario y divulgador científico.
El artículo Una nueva estimación del grosor de la corteza de hielo de Europa se ha escrito en Cuaderno de Cultura Científica.
Bost egitura kristalino desberdin autoantolatu dira lehen aldiz polimero bakar batean
POLYMAT-EHU buru duen nazioarteko partzuergo batek, polimero erdikristalinoetan orain arte behatu den autoantolaketa konplexuena aurkeztu du: bost bloke desberdin eta potentzialki kristalizagarri dituen polimero batek bere kabuz antolatzeko gaitasuna duela, barne-egitura erabat berria sortuz.
Aztertutako materiala bost polimero desberdinek osatzen dute: polietilenoa (PE), polietilen oxidoa (PEO), poli(ε-kaprolaktona) (PCL), poli(L-laktida) (PLLA) eta poliglikolida (PGA). Guztiak dira biobateragarriak eta hiru (PCL, PLLA eta PGA) biodegradagarriak. Bost bloke hauek esferulita berean integratzeak hainbat funtzio modu kontrolatuan bateratzea ahalbidetzen du.
 Irudia: EHUko ikerketan aztertutako materiala bost polimero desberdinek osatzen dute: polietilenoa (PE), polietilen oxidoa (PEO), poli(ε-kaprolaktona) (PCL), poli(L-laktida) (PLLA) eta poliglikolida (PGA). (Iturria: Matxinandiarena, Eider; et. al. (2025))
Irudia: EHUko ikerketan aztertutako materiala bost polimero desberdinek osatzen dute: polietilenoa (PE), polietilen oxidoa (PEO), poli(ε-kaprolaktona) (PCL), poli(L-laktida) (PLLA) eta poliglikolida (PGA). (Iturria: Matxinandiarena, Eider; et. al. (2025))Aplikazio potentzialak honako hauek dira:
- Medikuntza birsortzailea. Ehunen ingeniaritzarako egiturak diseinatzea, fasez fase degradatzen direnak: hasieran euskarri mekaniko sendoa emanez, eta ondoren bigunagoak diren faseak garatuz, ehunen birsorkuntza erraztuz.
- Farmakoen askapen kontrolatua. Bloke bakoitza bere desintegrazio-abiadura propioa duenez, sendagaiak une zehatz eta desberdinetan askatzeko aukera ematen dute.
- Teknologia aurreratuak. Egitura hierarkikoaren kontrolari esker ezaugarri mekaniko, termiko edo optiko erregulagarriak dituzten materialak garatzea, errendimendu handiko aplikazioetarako egokiak.
Nature Communications aldizkarian argitaratu den ikerketak zehaztasun eta zorroztasun metodologikoak jarraitu dit. Horretarako, karakterizazio aurreratuko teknikak erabili ziren, EHUko laborategietan, ALBA sinkrotroian eta Zaragozako Unibertsitatean eskuragarri daudenak. Neurketak zehatzak izan behar dira, sortzen diren kristalak elur-maluten kristalak baino gutxi gorabehera milioi bat aldiz txikiagoak direlako. Horrela, taldeak zehaztu zuen kristalizazioa modu sekuentzial eta hierarkikoan gertatzen dela: PGA → PLLA → PE → PCL → PEO
Bloke bakoitza aurrekoak sortutako egituran kristalizatzen da, materiala geruzaz geruza eraikiz. Kontrol hierarkiko horrek ez du soilik zein zatitan kristalizatzen den zehazten, baizik eta nola, noiz eta non, eta hori funtsezkoa da propietate funtzional aurreratuak dituzten materialak diseinatzeko.
Esferulitek Malta gurutze positiboaren eredu optiko bereizgarria erakusten dute, eta horrek adierazten du kate polimerikoak zentrotik kanporantz orientatzen direla, gurpil baten erradioen antzera. Antolaketa erradial horrek fase guztiek jarraitutasuna izatea bermatzen du, nahiz eta kimikoki desberdinak izan.
Iturria:EHU prentsa bulegoa: “Bost egitura kristalino desberdin autoantolatu dira lehen aldiz polimero bakar batean“.
Erreferentzia bibliografikoa:Matxinandiarena, Eider; Pérez-Camargo, Ricardo A.; Sebastián, Víctor; Zhang, Pengfei; Ladelta, Viko; Hadjichristidis, Nikos; Müller, Alejandro J. (2025). Can five chemically different lamellar crystals self-assemble in a single spherulite? Nature Communications, 16, 9873. DOI: 10.1038/s41467-025-64845-6
The post Bost egitura kristalino desberdin autoantolatu dira lehen aldiz polimero bakar batean appeared first on Zientzia Kaiera.
Una feroz batalla espacial… de microbios
Una caja de llena de virus y bacterias ha sido el sorprendente escenario de una fascinante batalla espacial tras completar su viaje de ida y vuelta a la Estación Espacial Internacional. Los contendientes en este enfrentamiento especial, mantienen una rivalidad ancestral y son adversarios desde hace miles de millones de años: la siempre temida bacteria Escherichia coli y su archienemigo viral, el bacteriófago T7.
 La Estación Espacial Internacional (ISS) Fuente: ESA
La Estación Espacial Internacional (ISS) Fuente: ESA
Por su parte, los fagos actúan como depredadores precisos: se adhieren a la superficie de la bacteria, inyectan su material genético y usan la maquinaria celular para multiplicarse. Si tienen éxito destruyen a la bacteria para liberar nuevas generaciones de virus. Por su parte, las bacterias no se quedan de brazos cruzados y también han desarrollado su propio arsenal de defensas. Algunas cambian la estructura de sus receptores para que los fagos no puedan engancharse, otras producen enzimas que destruyen el ADN viral, y algunas incluso registran fragmentos de virus en su propio genoma para reconocer y atacar futuras invasiones, un mecanismo con unas siglas (CRISPR) que seguro que os suenan.
Tradicionalmente esta batalla ocurre en la Tierra, pero un equipo de investigadores de la Universidad de Wisconsin-Madison, junto con la empresa biotecnológica estadounidense Rhodium Scientific Inc., han querido averiguar qué ocurriría con este enfrentamiento microscópico si se produjese en un entorno de microgravedad… o dicho de una manera más sencilla, en el año 2020 se envió una caja con virus y bacterias a la ISS y ahora, una vez que los contendientes han regresado a tierra firme, han publicado los resultados de su batalla espacial. Los científicos de la ISS incubaron diferentes combinaciones de bacterias y fagos durante 25 días, mientras que el equipo de investigación de bioquímicos mantuvo un grupo de control, con los mismos experimentos, en sus instalaciones de Madison, en la Tierra.
 Un fago sobre la superficie de una célula huésped. Fuente: Universidad de Wisconsin-Madison
Un fago sobre la superficie de una célula huésped. Fuente: Universidad de Wisconsin-MadisonPor supuesto, en el espacio la batalla no se detuvo, los virus siguieron infectando a las bacterias y la E. coli continuó con su férrea defensa… pero ambos rivales lo hicieron de una forma distinta a como lo hacen en la Tierra. El entorno de microgravedad influyó tanto en la evolución de los virus como en la de sus bacterias objetivo, impulsando cambios genéticos notables en ambos.
En el entorno de ingravidez de la estación, las bacterias fueron quienes hicieron el primer movimiento adquiriendo mutaciones en genes implicados en la respuesta microbiana al estrés y la gestión de nutrientes. Sus proteínas de superficie también cambiaron. Los fagos tuvieron un inicio algo más lento pero, finalmente, mutaron en respuesta para poder seguir uniéndose a sus víctimas. No obstante, esta respuesta tardía fue fulminante sobre todo si tenemos en cuenta sus posibles aplicaciones médicas: El equipo descubrió que ciertas mutaciones de fagos específicas del espacio eran especialmente eficaces para eliminar bacterias terrestres responsables de infecciones del tracto urinario. Si tenemos en cuenta que más del 90 % de las bacterias responsables de ITU son resistentes a los antibióticos, lo que convierte los tratamientos con fagos en una alternativa prometedora.
Es cierto que cuando pensamos en virus, solemos pensar en enfermedades… pero los fagos se han convertido en un gran aliado, especialmente en el grave problema de la resistencia microbiana. Desde principios del siglo XX, mucho antes de que los antibióticos se convirtieran en la regla general frente a las infecciones, científicos y médicos han explorado su potencial como terapia eficaz. Los resultados del este nuevo artículo nos ofrecen una nueva ventana para desarrollar tratamientos eficaces y incorporar esas mejoras espaciales a nuestros fagos terrestres: «El espacio modifica radicalmente la interacción entre fagos y bacterias: la infección se ralentiza y ambos organismos evolucionan siguiendo una trayectoria distinta a la de la Tierra. Al estudiar estas adaptaciones espaciales, hemos desarrollado nuevos conocimientos biológicos que nos han permitido diseñar fagos con una actividad muy superior contra patógenos resistentes a los fármacos en la Tierra».
Con la experiencia adquirida durante este primer experimento, los investigadores están trabajando ya en un segundo experimento (que por supuesto debe caber en la misma caja pequeña) para un futuro lanzamiento espacial. «Primero, nos hemos planteado preguntas básicas de microbiología aplicada al espacio», explica uno de los autores, «ahora estamos listos para estudiar sistemas de múltiples fagos y bacterias que representan con mayor precisión la complejidad del microbioma humano y averiguar qué interacciones novedosas ocurren en el espacio y qué podemos aprender de ellas aquí en la Tierra».
Referencias científicas y más información:
Phil Huss, Srivatsan Raman, et al. (2026) Microgravity reshapes bacteriophage–host coevolution aboard the International Space Station PLOS Biology doi: 10.1371/journal.pbio.3003568
Renata Solan (2026) Microbes mutated in space hint at biomedical benefits to humans on Earth Universidad de Wisconsin-Madison
PLOS (2026) Scientists sent viruses to space and they evolved in surprising ways Science Daily
Manuela Callari (2026) Viruses that evolved on the space station and were sent back to Earth were more effective at killing bacteria Live Science
Sobre el autor: Javier «Irreductible» Peláez es escritor y comunicador científico. Autor de «500 Años de Frío» (2019) y «Planeta Océano» (2022). Es ganador de tres premios Bitácoras, un premio Prisma a la mejor web de divulgación científica y un Premio Ondas al mejor programa de radio digital.
El artículo Una feroz batalla espacial… de microbios se ha escrito en Cuaderno de Cultura Científica.
Sara Bandrés Ciga: «Gure DNA ezagutzeak prebentziora eta tratamendu pertsonalizatu eraginkorragoetara hurbiltzen gaitu»
Sara Bandrés Ciga doktorea farmazialaria eta genetista molekularra da. Bere ikerketa jardueraren helburua da bariazio genetikoak gaixotasun neurodegeneratiboetan nola eragiten duen ulertzea, arrisku etiologikoaren espektroan zehar, forma monogenikoetatik hasi eta esporadiko konplexuetaraino. 2013 eta 2016 bitartean doktorego tesia Granadako Unibertsitatean egin zuen, eta Parkinson gaixotasunaren oinarri genetikoak izan zituen ardatz. 2017tik 2025era, Osasun Institutu Nazionaletako (NIH) Zahartzearen Institutu Nazionalean (National Institute on Aging) lan egin zuen, Marylanden (AEB). Bertan, doktoratu osteko ikertzaile, senior zientzialari eta neurogenetika ataleko zuzendari izan zen. Gaur egun Valo Health bioteknologiako enpresan senior ikertzailea da, eta erakundea eskala handiko datuei aplikatutako adimen artifizialean oinarritutako garapen farmakologikoan espezializatuta dago.
Sarak dibulgazio zientifiko eta prestakuntzarako grina handia du, eta bi arloetan aktiboki parte hartzen du.
 Irudia: Sara Bandrés Ciga ikertzailea. (Argazkia: Sara Bandrés Cigak emana)Zein da zure ikerketa arloa?
Irudia: Sara Bandrés Ciga ikertzailea. (Argazkia: Sara Bandrés Cigak emana)Zein da zure ikerketa arloa?
Gaixotasun neurodegeneratiboen genetika ikertzen dut, eta nire helburua da ulertzea genomaren eremu jakin batzuk nola eragiten dieten patologia horien arriskuari eta bilakaerari. Azkenaldian, nire lanak gorputzaren sistema desberdinetako datu omikoak konbinatzea izan du helburu, hala nola heste-garun ardatza, garuna modu isolatuan baino modu global eta konektatuan aztertzeko.
Zergatik aritzen zara arlo horretan?Genetika tresna gakoa da gaixotasun horiek eragiten dituzten mekanismoak argitzeko. Gure DNA ezagutzeak prebentziora eta tratamendu pertsonalizatu eraginkorragoetara hurbiltzen gaitu. Genetistaren filosofiaren arabera, arrisku genetikoa zenbat eta egokiago definitu, orduan eta hobeto ulertuko ditugu gaixotasunaren mekanismo molekularrak.
Izan al duzu erreferentziazko figurarik zure ibilbidean?Bai, John Hardy, zalantzarik gabe. Izan ere, alzheimerraren mekanismo molekularrei buruzko bere lan aitzindaria ezinbestekoa izan da gaixotasun hori eta bestelako gaixotasun neurodegeneratiboak ikertzeko. Duela hamaika urte bere laborategian aritzeko aukera izan nuen University College London (UCL) unibertsitatean, eta jarraibide ederra izan zen niretzat, nire ibilbide profesionala Estatu Batuetara bideratzeko.
Zer aurkitu edo konpondu nahiko zenuke zure arloan?Gustatuko litzaidake genetikak arriskua identifikatzen laguntzea ez ezik, gaixotasuna garatzea eragiten duten prozesuak sakon ulertzen laguntzea ere. Espero dut ezagutza honek aurreikuspen estrategiak eta esku hartze goiztiar eta pertsonalizatua sortzeko aukera ematea, sintomak agertu aurretik pertsonen bizitza hobetu ahal izateko.
Zer aholku emango zenioke ikerketaren munduan hasi nahi duen norbaiti?Saiatuak izateko esango nieke. Ikerketa abiadura lasterketa baino, iraupeneko lasterketa da. Emaitzak oso gutxitan antzeman daitezke epe laburrean, baina jarraikitasuna, pazientzia eta grina erakutsiz, inpaktu handiko ekarpenak lor daitezke.
Jatorrizko elkarrizketa Mujeres con Ciencia blogean argitaratu zen 2025eko azaroaren 22an: “Sara Bandrés Ciga: «Conocer nuestro ADN nos acerca a la prevención y a tratamientos personalizados más efectivos»“.
Itzulpena: EHUko Euskara Zerbitzua.
Ikertzen dut atalak emakume ikertzaileen jardunari erreparatzen die. Elkarrizketa labur baten bidez, zientzialariek azaltzen dute ikergai zehatz bat hautatzeko arrazoia zein izan den eta baita ere lanaren helburua.
The post Sara Bandrés Ciga: «Gure DNA ezagutzeak prebentziora eta tratamendu pertsonalizatu eraginkorragoetara hurbiltzen gaitu» appeared first on Zientzia Kaiera.
La teoría del invariante

Existen muchas formas de explicar la teoría de la relatividad de Einstein. Así, por ejmplo, en nuestra serie Teoría de la invariancia se explica paso a paso y usando muy pocas matemáticas, y las que se usan, elementales. Pero esta síntesis que hace Francis Villatoro en 10 minutos (La teoría del invariante) es, simplemente, magnífica, pues incluye también aspectos geométricos que no se suelen tratar a este nivel.
Francisco Román Villatoro Machuca es profesor titular (acreditado como catedrático) del Departamento de Lenguajes y Ciencias de la Computación de la Universidad de Málaga. Es licenciado en Informática, licenciado en Física y doctor en Matemáticas. Es un divulgador de referencia en el mundo hispanohablante.
Edición realizada por César Tomé López
El artículo La teoría del invariante se ha escrito en Cuaderno de Cultura Científica.
Nola funtzionatzen du hozkailu batek?
Elikagaiak freskoan gordetzea ezinbestekoa da azkar ez usteltzeko eta seguru kontsumitzeko. Horretarako erabiltzen dugun tresna nagusietako bat hozkailua da, egunero ia konturatu gabe erabiltzen dugun gailua. Baina nola lortzen du barrualdea hotz mantentzea? Hozkailuak ez du hotza sortzen… beroa kentzen du, eta hor dago gakoa.
Bideo honetan ikusiko dugu nola funtzionatzen duen hozkailu baten barruko hozte-sistemak: fluido batek egoeraz aldatuz beroa nola xurgatzen duen, nola botatzen duen kanpora eta nola kontrolatzen duen guztia termostato batek. Prozesu etengabe eta zehatz bati esker, elikagaiak denbora gehiagoz egoera onean mantentzen dira.
Zergatik gertatzen dira gauzak Ikusgela hezkuntza proiektuaren bideo-sorta bat da. Euskal Wikilarien Kultur Elkartearen ikus-entzunezko egitasmoa da eta EHUko Kultura Zientifikoko Katedraren laguntza izan du.
The post Nola funtzionatzen du hozkailu batek? appeared first on Zientzia Kaiera.
¿Comemos lo que decimos que comemos?
 Foto: Artem Podrez / Pexels
Foto: Artem Podrez / Pexels¿Y si una simple gota de sangre pudiera decirnos si nos estamos alimentando bien? Aunque muchas personas afirman seguir una dieta saludable, los métodos tradicionales para medir lo que comemos –como encuestas o diarios alimentarios– no siempre son fiables. Al fin y al cabo, es fácil olvidar lo que hemos comido o incluso tener percepciones erróneas sobre las cantidades ingeridas.
Por suerte, ahora hay alternativas. En un estudio que llevamos a cabo en el centro tecnológico AZTI, analizamos si una pequeña muestra de sangre recogida del dedo (lo que se llama dried blood spot o DBS) puede reflejar con precisión lo que comemos, especialmente respecto al consumo de pescado azul, rico en grasas saludables omega-3.
El estudio incluyó 18 participantes, hombres y mujeres de entre 18 y 65 años, sin enfermedades. Durante cinco semanas, las 18 personas participaron en una intervención nutricional. Primero siguieron su dieta habitual, luego evitaron el pescado y finalmente consumieron caballa enlatada varias veces por semana. En cada fase, recogimos muestras de sangre y analizamos los niveles de diferentes ácidos grasos.
De los cuestionarios a la analítica objetivaLos resultados fueron claros. Antes de comenzar la intervención, el perfil de ácidos grasos reveló distintos patrones de dieta entre los participantes.
Por un lado, aquellas personas que habitualmente consumían lácteos azucarados, bebidas carbonatadas y azúcar presentaron mayores niveles de grasas omega-6 y menores niveles grasas omega-3. Esto es importante porque cuando el omega-6 está descompensadamente elevado, el riesgo de fallecer aumenta. Por el contrario, quienes consumían pescado azul, bebidas alcohólicas fermentadas, edulcorantes y nueces presentaron mayores niveles de grasas monoinsaturadas y omega-3.
Un tercer grupo con mayor consumo de verduras, cereales integrales, quesos y mantequilla presentó niveles intermedios de omega-3 y omega-6, y niveles más altos de grasas saturadas.
Pero ¿cuánto tardan en cambiar nuestro perfil de ácidos grasos tras consumir ciertos alimentos? Menos de lo que imaginamos. En los experimentos vimos que si los sujetos consumían latas de caballa, los niveles en sangre de ciertos omega-3 como el EPA aumentaban en un día. Sin embargo, otros como el DHA tardaban más en reflejarse. Esto demuestra que esta técnica puede detectar cambios en la dieta tanto a corto como a largo plazo.
Además, los niveles de estas grasas cambiaban de manera distinta según el patrón de dieta habitual de cada participante. En los participantes que normalmente no consumían pescado azul, aumentaban más sus niveles de EPA al día siguiente de comer pescado. Sin embargo, aunque el DHA también aumentó en estos participantes durante las dos semanas de intervención, los niveles no llegaron a igualarse a los de los participantes que normalmente sí consumían pescado. Esto quiere decir que para adquirir niveles de omega-3 correspondientes con un consumo de pescado azul adecuado, necesitarían seguir tomándolo durante más de dos semanas.
Identificar si la dieta es adecuada sin cuestionariosEl nuevo método es, sobre todo, rápido, cómodo y poco invasivo. No requiere de profesionales médicos y puede aplicarse fácilmente en grandes muestras, o incluso en casa. Además, permite identificar si la dieta es adecuada y evitar los errores comunes de los cuestionarios alimentarios, que muchas veces no reflejan lo que realmente comemos. Por otro lado, gracias a los cambios a corto y largo plazo de diferentes grasas, también nos permite saber si las personas siguen las pautas indicadas en un plan nutricional.
Esta investigación nos coloca un paso más cerca de ofrecer recomendaciones nutricionales realmente personalizadas. Porque al final lo que importa no es lo que decimos que comemos, sino lo que realmente comemos.![]()
Sobre las autoras: Laura García-Urtiaga, Investigadora Predoctoral en Nutrición de Precisión – AZTI, Universidad del País Vasco / Euskal Herriko Unibertsitatea and Sara Arranz, Investigadora del grupo de Alimentación y Salud de AZTI
Este artículo fue publicado originalmente en The Conversation. Artículo original.
El artículo ¿Comemos lo que decimos que comemos? se ha escrito en Cuaderno de Cultura Científica.
Belabeltzek Geometria gainditzen dute
Baliteke matematiketan trebeak ez galera pentsatzea, baina gizakiok sen matematiko zorrotza daukagu, gure bizitzan oso goiz azaleratzen dena. Gizakiak ez diren animaliek ere badute nolabaiteko gaitasun matematikoa, askoz mugatuagoa bada ere. Adibidez, frogatu egin da hegazti eta ugaztun batzuek zenbakien nolabaiteko sena badutela. Baieztapen hori zenbait esperimenturen bidez frogatu da, hala nola sariak jasotzea tekla bat hainbat aldiz sakatu ostean, edo objektu edo zentzumen-estimulu kopuru jakin bat antzeman ondoren. Hona hemen eredu esperimental horien azterketa bat.
Gizakienak ez diren gaitasun matematiko horiek aritmetikaren arlokoak dira. Hala ere, geometriaren arloan askoz gutxiago ezagutzen ditugu gizakiak ez diren animalien trebetasunak. Egia da hegazti batzuek bikotea aukeratzen dutenean simetriaren balorazioak baduela zerikusia, 90eko hamarkadaren hasieran egindako lan aitzindari batek erakutsi bezala. Bikotea aukeratzerakoan gorputzeko simetriaren balio positiboa animalien espezie askotara hedatu da, arrainetara barne. Erleek ere erakutsi dute loreen simetria hautemateko gai direla.
Hala ere, beste propietate geometriko batzuk hautemateko gaitasuna, hala nola paralelismoa, elkarzutasuna edo luzera erlatiboa, baliteke soilik gizakiena izatea. Hori iradoki zuen duela gutxi egindako azterlan batek, babuinoekin eta adin eta jatorri desberdineko gizakiekin egindakoa; zehazki, Europakoak eta Himbak (Namibia eta Angolako tribu erdinomadak). Gizaki guztiek babuinoek hautematen ez zituzten erregulartasun geometrikoak hautemateko gai izan ziren.
 1. irudia: belabeltza (Corvus corone). (Iturria: B.S. Thurner Hof – CC BY-SA 3.0 lizentziapean. Iturria: Wikimedia Commons)
1. irudia: belabeltza (Corvus corone). (Iturria: B.S. Thurner Hof – CC BY-SA 3.0 lizentziapean. Iturria: Wikimedia Commons)Baliteke erregulartasun geometrikoak hautemateko gaitasuna giza espeziearen berezitasun propioa izatea? Bada, ideia hori zalantzan jarri du Tubingako Unibertsitateko (Alemania) talde batek bere ikerketan, eta, horretarako, belabeltzak (Corvus corone) erabili dituzte. Belabeltza (1. irudia) korbido espezie bat da; dagoeneko frogatu da problemak ebazteko gaitasun handia duela, bai eta gaitasun numerikoa ere.
 2. irudia. testuan deskribatutako esperimentuaren eskema. Belabeltzak desberdina den forma hautemateko entrenatu zituzten (goian). % 75etik gorako arrakasta-tasa lortu zutenean, sei laukien artean bestelako geometria zuena hautatzeko aukera eman zitzaien (behean). (Iturria: Schmidbauer,Philipp; et al. (2025) – CC BY-4.0. lizentziapean.)
2. irudia. testuan deskribatutako esperimentuaren eskema. Belabeltzak desberdina den forma hautemateko entrenatu zituzten (goian). % 75etik gorako arrakasta-tasa lortu zutenean, sei laukien artean bestelako geometria zuena hautatzeko aukera eman zitzaien (behean). (Iturria: Schmidbauer,Philipp; et al. (2025) – CC BY-4.0. lizentziapean.)Esperimentu hori gizaki eta babuinoekin egindakoaren antzekoa zen. Hala ere, bi belabeltz helduk hartu zuten parte, eta pantaila ukigarri batean bost objektu berdin (izarrak adibidez) eta desberdina zen beste bat (ilargi erdia, adibidez) erakutsi zizkieten. Hegaztiek azkar ikasi zuten mokoarekin desberdina zen irudia hautatuz gero, saria jasotzen zutela (2. irudia).
 3. irudia: esperimentuan erabilitako laukien ereduak. Erreferentzia eta bariazioa ikus daiteke. Ezkerreko zutabean erreferentzia bost aldiz errepikatzen da, eta tamaina eta errotazioa desberdina da. Eskuineko zutabean bariazioa errepikatzen da, eta erreferentzia, berriz, desberdina da. Geziek erantzun zuzena markatzen dute. (Iturria: Schmidbauer,Philipp; et al. (2025) – CC BY-4.0. lizentziapean.)
3. irudia: esperimentuan erabilitako laukien ereduak. Erreferentzia eta bariazioa ikus daiteke. Ezkerreko zutabean erreferentzia bost aldiz errepikatzen da, eta tamaina eta errotazioa desberdina da. Eskuineko zutabean bariazioa errepikatzen da, eta erreferentzia, berriz, desberdina da. Geziek erantzun zuzena markatzen dute. (Iturria: Schmidbauer,Philipp; et al. (2025) – CC BY-4.0. lizentziapean.)Belabeltzak entrenatu ostean, lauki mota desberdinak erakusten zituzten sei irudi erakutsi zizkieten (karratuak, laukizuzenak, erronboak, trapezioak eta trapezoideak). Horietako bost berdin berdinak ziren angelu eta aldeen proportzioari dagokionez, baina tamaina desberdina zen edo biratuta zeuden (3. irudia). Seigarren laukia antzekoa zen, baina angeluetan aldea zegoen; hortaz, aldeen arteko proportzioa desberdina zen. Belabeltzei sei segundo eman zizkieten desberdina zen irudia detektatzeko.
Belabeltzek ausaz aukeratu izan balute, asmatutakoen ehunekoa % 16,7koa izango litzateke (1/6). Ehuneko horren batezbestekoa, berriz, % 50 izan zen belabeltzetako baten kasuan, eta % 60koa bestearen kasuan. Hau da, belabeltzek lauki mota desberdinen geometriaren arteko aldeak antzeman zituzten, tamainaren eta posizioaren arteko aldea gainditu ondoren. Hala ere, lauki mota guztiak ez zituzten berdin hauteman. Laukien arteko bariazioak ia beti hauteman zituzten (% 90), baina erronboak zailago hauteman zituzten (% 25-30).
Bestalde, interesgarria izan zen esperimentuaren errepikapen askotan ikusi zela erantzun zuzenen ehunekoak gora egin zuela pixka bat, baina igoera hori ez zela estatistikoki esanguratsua izan. Beste era batera esanda, belabeltzek dagoeneko bazeukaten formen propietate geometrikoak hautemateko gaitasuna, baina entrenamenduaren bidez gaitasun hori hobetu zezakeen.
Esperimentu hori garrantzitsua da, izan ere, gizakia ez den animalia batek propietate geometrikoak hautemateko gaitasuna duela erakutsi da lehenengo aldiz, eta, hortaz, frogatu da gaitasun hori modu independentean bereganatu ahal izan dela hainbat leinu ebolutibotan.
Erreferentzia bibliografikoa:Schmidbauer, Philipp; Hahn, Madita; Nieder, Andreas (2025). Crows recognize geometric regularity. Science Advances, 11,15. DOI: 10.1126/sciadv.adt3718.
Egileaz:Ramón Muñoz-Chápuli Oriol Animalien Biologiako Katedraduna (erretiratua) da Malagako Unibertsitatean.
Jatorrizko artikulua Cuaderno de Cultura Científica blogean argitaratu zen 2025eko maiatzaren 5ean: “Las cornejas negras aprueban en Geometría“.
Itzulpena: EHUko Euskara Zerbitzua.
The post Belabeltzek Geometria gainditzen dute appeared first on Zientzia Kaiera.
Geología sobre esquís
Durante estas semanas están teniendo lugar los Juegos Olímpicos de Invierno en Italia, gracias a los cuales, y aquí reconozco mi ignorancia deportiva, podemos disfrutar de un montón de deportes y modalidades que no sabía ni que existían. Aunque, y de nuevo me sincero, no consigo centrarme en seguir el desarrollo de las pruebas al aire libre porque me dedico a prestarle más atención al paisaje que rodea las pistas olímpicas. Pero esta vez no me siento tan culpable, porque incluso en el vídeo corto que sirve como entradilla en la retrasmisión televisiva de las competiciones, unas montañas cobran todo el protagonismo: las Dolomitas.
 Captura de pantalla del vídeo de entradilla de las pruebas deportivas con las montañas Dolomitas resaltadas en el centro de la imagen. Fuente. Fotograma tomado de RTVE
Captura de pantalla del vídeo de entradilla de las pruebas deportivas con las montañas Dolomitas resaltadas en el centro de la imagen. Fuente. Fotograma tomado de RTVELas Dolomitas son una serie de cordilleras montañosas situadas al sur de los Alpes orientales, en el norte de Italia, y su importancia en estos Juegos Olímpicos radica en que la segunda sede principal, Cortina d´Ampezzo, se sitúa al pie de estas montañas. Pero no es la única, hasta otras cinco localidades emplazadas en las Dolomitas albergan instalaciones en las que se desarrollan los deportes de estos juegos. Todo ello debido a que las laderas y valles dolomíticos son una de las principales zonas europeas para disfrutar de los deportes invernales gracias, como no, a su geología.
 Localización de las Dolomitas al norte de Italia (enmarcadas dentro del círculo rojo) y de las sedes de los Juegos Olímpicos de Invierno situadas en las laderas de sus montañas. Fuentes: Mapa topográfico tomado de Google Maps, la localización de las sedes deportivas está tomada de Olympics.
Localización de las Dolomitas al norte de Italia (enmarcadas dentro del círculo rojo) y de las sedes de los Juegos Olímpicos de Invierno situadas en las laderas de sus montañas. Fuentes: Mapa topográfico tomado de Google Maps, la localización de las sedes deportivas está tomada de Olympics.Esta historia comienza hace unos 250 millones de años, en un Periodo geológico llamado Triásico. En aquella época, el supercontinente Pangea aún estaba unido y esta zona de Italia era un mar tropical poco profundo, con aguas cálidas y muy transparentes, en los que vivían algas y otros pequeños organismos con caparazones carbonatados. Esta paz se rompió ligeramente cuando comenzó la rotura de Pangea, hace unos 238 millones de años, porque produjo una serie de erupciones volcánicas submarinas en esta área, depositándose rocas volcánicas entre el barro carbonatado. Pero después de la tormenta llegó otra vez la calma, desarrollándose un nuevo mar tropical tranquilo en el que crecieron abundantes arrecifes de coral. Aunque no duró mucho, ya que, a comienzos del Periodo Jurásico, hace entre unos 200 y unos 180 millones de años, el agua se retiró ligeramente, quedando este lugar como una zona costera con amplias playas por las que paseaban dinosaurios. Sin embargo, el mar no se rindió y recuperó sus dominios, apareciendo así, desde hace unos 180 millones de años hasta finales del Cretácico, una nueva zona marina, más profunda que la anterior, en la que los ammonites fueron los organismos carbonatados protagonistas.
La idílica imagen de mares tropicales se acabó hace unos 65 millones de años, cuando la placa tectónica Africana empezó a moverse hacia el norte, chocando con la placa tectónica Euroasiática. Este empuje produjo que todas las rocas que se formaron desde el Triásico hasta el Cretácico empezaran a ascender, doblándose y fracturándose sin parar. Así, sin prisa pero sin calma, el choque de placas provocó que, en los últimos 10 millones de años, se formasen las enormes elevaciones que hoy conocemos como las Dolomitas. Y, como broche final de esta historia, en los últimos 2 millones de años, los agentes meteorológicos como la lluvia, el viento o las lenguas de hielo que bajaban por las laderas de las montañas, fueran esculpiendo el paisaje actual: crestas, valles y acantilados de paredes casi verticales.
Si me habéis leído en otras ocasiones, seguro que esta historia no os sorprende, porque os la habré contado antes. De hecho, podría valer para muchísimas de las cordilleras más conocidas del mundo, como los Alpes, los Pirineos, los Cárpatos o, incluso, el Himalaya. Entonces, ¿qué hace especial a las Dolomitas? Pues la respuesta a esta pregunta se encuentra en su propio nombre.
 Cristales de dolomita encontrados en la cantera de Azcárate (Eugui, Navarra). Fotografía de Didier Descouens / Wikimedia Commons
Cristales de dolomita encontrados en la cantera de Azcárate (Eugui, Navarra). Fotografía de Didier Descouens / Wikimedia CommonsEl barro marino carbonatado que se depositó durante el Triásico tenía calcio y magnesio y acabó convirtiéndose en un mineral llamado dolomita (CaMg(CO3)2), que es el componente principal de la roca conocida como dolomía. Pues es tal la abundancia de este mineral en los Alpes orientales, que fue aquí donde lo descubrió a finales del siglo XVIII un geólogo francés apellidado Dolomieu. Y sí, el nombre del mineral es un homenaje a su descubridor.
Pero aquí no termina su particularidad. A diferencias del Triásico, el barro marino carbonatado formado durante el Jurásico y el Cretácico sólo tenía calcio, generando el mineral calcita (CaCO3) que forma las rocas calizas. Y resulta que la dolomita es un mineral con mayor dureza que la calcita, lo que provoca que la roca dolomía sea más resistente a la acción de los elementos que la caliza, las rocas volcánicas y la arenisca formada a partir de la arena de las playas jurásicas. Por este motivo, las Dolomitas han quedado cinceladas como enormes picos verticales que destacan sobre el paisaje circundante, haciendo que se nos desvíe la vista de las pruebas de esquí a la belleza de las montañas que rodean las pistas.
Y he dejado lo mejor para el final. Gracias a la presencia del magnesio en su composición, la dolomita es un mineral capaz de reflejar la luz solar, provocando, tanto al amanecer como al atardecer, un efecto óptico que confiere unas tonalidades rosadas o violáceas a las montañas de las Dolomitas y que se conoce como “alpenglow” (resplandor alpino) en alemán, o “enrosadira” en italiano. Un motivo más para seguir por televisión los Juegos Olímpicos de Invierno… aunque seguiré sin prestarle atención a los deportes por culpa de la belleza del paisaje en donde se desarrollan.
 Efecto de la “enrosadira” en las Dolomitas. Foto: Anna Marchenkova /Wikimedia Commons
Efecto de la “enrosadira” en las Dolomitas. Foto: Anna Marchenkova /Wikimedia Commons
Sobre la autora: Blanca María Martínez es doctora en geología, investigadora de la Sociedad de Ciencias Aranzadi y colaboradora externa del departamento de Geología de la Facultad de Ciencia y Tecnología de la EHU
El artículo Geología sobre esquís se ha escrito en Cuaderno de Cultura Científica.
Claudia Joan Alexander, espazioaren eta zientziaren hezkuntzan aitzindaria
Claudia Joan Alexander (1959-2015) zientzialari kanadiar-estatubatuar nabarmena izan zen, geofisikan eta planetologian espezializatua. Lorpen zientifikoetatik haratago, emakumeen eta gutxiengoen defendatzailea izan zen STEM alorretan eta komunikatzaile zientifiko sutsua.
Claudia Joan Alexander 1959ko maiatzaren 30ean jaio zen Vancouverren (Kanada), nahiz eta familia Silicon Valleyra (Kalifornia, AEB) joan zen bera jaio eta hilabete gutxira. Ama korporazioko liburuzaina izan zen Intel multinazional teknologikoan, eta aita gizarte langilea zen; neba bat eta ahizpa bat zituen. Claudia izan zen zuriak nagusi ziren eskolako neska beltz bakanetakoa; hori zela eta, nahiko bakarrik eta isolatuta sentitu zen haurtzaroan. Irakurketan babestu zen, eta kazetari izatea zuen amets.
 1. irudia: Claudia Joan Alexander zientzialari kanadiar-estatubatuar nabarmena izan zen, geofisikan eta planetologian espezializatua. (Iturria: NASA)
1. irudia: Claudia Joan Alexander zientzialari kanadiar-estatubatuar nabarmena izan zen, geofisikan eta planetologian espezializatua. (Iturria: NASA)Gurasoek, ordea, alabak zerbait “baliagarria” ikas zezan nahi zuten, ingeniaritza, esaterako. Uda batez, NASAren Ames Ikerketa Zentroko ingeniaritza-sailean hasi zen aldi baterako lanean. Han izan zuen planetologiaren berri, eta berak uste baino errazagoa eta liluragarriagoa zen arlo bat ezagutu zuen. Artizarrera Pioneer misioa egin zuten garaia zen, eta Voyager zundak kanpoko eguzki sisteman zehar ibili ziren garaia.
Ibilbide akademiko bikaina eta ibilbide profesionalaren hasieraGeofisikako –Lurra fisikaren ikuspegitik aztertzen duen zientzia– lizentziatura lortu zuen Alexanderrek Kaliforniako Unibertsitatean, Berkeleyn, 1983an. Ikasten jarraitu zuen eta geofisika eta fisika espazialeko maisutza-gradua egin zuen Kaliforniako Unibertsitatean, Los Angelesen. 1985ean amaitu zuen. Masterreko tesian Artizarreko ionosferako muturreko erradiazio ultramoreko eguzki-bariazioak sakonago aztertu zituen, Pioneer orbitatzailearen datuak erabilita. Handik urte batzuetara, 1993an, Zientzia Atmosferiko, Ozeaniko eta Espazialetako doktoregoa lortu zuen Michigango Unibertsitatean, eta espazioko plasmaren fisikan espezializatu zen.
Handik gutxira hasi zuen ibilbide profesionala Ameriketako Estatu Batuetako Geologia Zerbitzuan plaken tektonika aztertzeko kontratuarekin. NASAra itzuli zen gero, Ames Ikerketa Zentrora zehatz esateko, eta Jupiterren ilargiak behatu zituen. 1986an NASAk Kalifornian zuen Zurrusta Propultsio Laborategira (Jet Propulsion Laboratory, JPL) joan zen, NASArentzat tripulaziorik gabeko espazio-ontziak eraikitzen eta martxan jartzen dituen zentrora. Ia hogeita hamar urte egin zituen han, hil zen arte.
Urteen poderioz Claudia Alexander damutu egin zen lan munduan sartzerako doktoratu ondoko bat egin ez izanaz, bere ustez etapa hori “funtsezkoa da galdera zientifiko bakarrean kontzentratu eta ibilbide batean behar diren oinarriak finkatzeko argitalpenak sortzeko”, eta hori egitea oso zaila da lan munduan, hainbat egiteko baitzuen eta denbora gutxiegi guztiak egiteko.
Zurrusta Propultsio Laborategia: Galileo, Rosetta eta CassiniJPLko misio espazialekin zuen konpromisoa ia berehalakoa izan zen. Galileo espazio-ontziko plasma-uhinen tresnaren koordinatzaile zientifikoa izan zen, 2003an amaitu zen misioaren azken faserako proiektuaren buru izan aurretik. Jupiterren atmosferako datuak bildu zituen, beste 21 ilargi aurkitu zizkioten planetari eta Ganimedes sateliteak azalerari lotutako exosfera bat duela jakin zuten; beraz, ordura arte ilargi inaktiboa zela uste zen arren, ideia hori berriro aztertu egin behar izan zuten. Alexanderrek bereziko garrantzia izan zuen misio horretako baliabide teknikoak eta giza baliabideak kudeatzerakoan eta datuak interpretatzerakoan.
 2. irudia: Claudia Joan Alexander emakumeen eta gutxiengoen defendatzailea izan zen STEM alorretan. (Argazkia: NASA – jabari publikoa. Iturria: Wikimedia Commos)
2. irudia: Claudia Joan Alexander emakumeen eta gutxiengoen defendatzailea izan zen STEM alorretan. (Argazkia: NASA – jabari publikoa. Iturria: Wikimedia Commos)2000. urtetik 2015ean hil zen arte, Europako Espazio Agentziaren –ESA, ingeleseko siglengatik– Rosetta misioari NASAk egindako ekarpenaren arduraduna izan zen Claudia; misio horren egitekoa 67P/ Churyumov –Gerasimenko kometa aztertu eta kometa horretan lurreratzea zen. Bere arduren artean zegoen 35 milioi dolarreko tresnak gainbegiratzea eta NASAren Espazio Sakoneko Saretik jarraipena eta nabigazioa egitea. Lankidetzarako ikuspegia izateari esker, Alexanderrek hainbat herrialde eta diziplinatako talde zientifikoak uztartzea lortu zuen.
Galileo eta Rosettaz gain, Alexanderrek Saturnora egindako Cassini-Huygens misioari ere ekarpenak egin zizkion, eta bere egin zituen komunikaziorako eta dibulgaziorako egitekoak, Saturnoren inguruko zientziaren ezagutza sakona behar baitzen.
Alexander Ameriketako Estatu Batuetako Geofisikako Batasuneko kide izan zen, non dibertsitatearen batzordeko buru izan baitzen, hezkuntzan eta Lurraren eta espazioaren dibertsitatean oinarrituz. Emakume Geozientzialarien Elkarteko kide ere izan zen.
Gutxiengoen defendatzailea STEM arloetanZientzia eta komunikazioa banaezinak ziren berarentzat: inspiratzea zuen xede. Claudia Alexander emakumeen eta gutxiengoen defendatzailea izan zen zientzia, teknologia, ingeniaritza eta matematiken (STEM) alorretan; Michigango Unibertsitatean ikasle gazteen mentorea izan zen, bereziki STEM interesatzen zitzaien emakume gazte beltzena; goi-mailako ikasketetan jarraitzera sustatu zituen eta diziplinan ordezkaritza zutela sentitzera. Zientzialari honek zientzian ez ezik, ahalduntzen lagundu zien haien bizitzetan ere arrastoa utzi zuen.
Arlo profesionaletik harago, idaztea ikaragarri gustatzen zitzaion Alexanderri. Haurrentzako liburuak idatzi zituen, eta zientzia fikzioan sartzen ere ausartu zen. Idazteaz gain, tenisean jolastea gustatzen zitzaion, zaldian ibiltzea eta bidaiatzea.
Hainbat izendapen eta aintzatespen jaso zituen bizi zela, esaterako: University of Michigan Woman of the Year Giza Harremanetan (1993), Zientzia Atmosferiko, Ozeaniko eta Espazialetako ikasle ohien merezimenduaren saria (2002), eta Emerald Honor for Women of Color in Research & Engineering (2003). 2007an Claudia Alexander beka ematen hasi ziren bere ohorez, Michiganeko Unibertsitateak baliabide mugatuak dituzten ikasleei ematen dien laguntza zientzia klimatiko eta espazialetan eta/edo ingeniaritzan espezializa daitezen.
 3. irudia: Rosetta misioko zientzialariek 67P/ Churyumov-Gerasimenko kometaren ezaugarrietako bati C. Alexander Gate izena jarri zioten bere ohorez. (Iturria: NASA)
3. irudia: Rosetta misioko zientzialariek 67P/ Churyumov-Gerasimenko kometaren ezaugarrietako bati C. Alexander Gate izena jarri zioten bere ohorez. (Iturria: NASA)Claudia Joan Alexander 2015eko uztailaren 11n hil zen bularreko minbiziaren ondorioz, hamar urtez gaixotasunaren aurka borrokan aritu ondoren. 2015ean betikotu zuten bere legatua, Rosetta misioko zientzialariek 67P/ Churyumov-Gerasimenko kometaren ezaugarrietako bati C. Alexander Gate izena jarri ziotenean bere ohorez. Michigango Unibertsitateak eta AEBko Elkarte Astronomikoko Planetologiako Atalak urtero ematen dituzte sariak bere oroimenez.
Iturriak- Betz, Eric (2015). Pioneering Rosetta mission scientist Claudia Alexander dead at 56, Astronomy Magazine, 2015eko uztailaren 13a
- Singer, Kelsi (2011). Claudia Alexander: Be prepared to be flexible in your career, Women in planetary Science, 2011ko otsailaren 3a
- 67P/Churiumov-Guerasimenko, Wikipedia
- Gombosi, T. I. (2016). Claudia Joan Alexander (1959–2015), EOS, 2016ko urtarrilaren 12a
- Claudia Alexander, Wikipedia
Edurne Gaston Estanga elikagaien zientzia eta teknologiako doktorea da. Gaur egun, zientzia eta teknologiaren ezagutza zabaltzea sustatzen duten erakundeen proiektuak kudeatzen ditu.
Jatorrizko artikulua Mujeres con Ciencia blogean argitaratu zen 2025eko uztailaren 24an: “Claudia Joan Alexander, pionera en la educación espacial y científica”.
Itzulpena: EHUko Euskara Zerbitzua.
The post Claudia Joan Alexander, espazioaren eta zientziaren hezkuntzan aitzindaria appeared first on Zientzia Kaiera.
Las diez matemáticas de la Torre Eiffel
Eduardo Galeano (1940-2015) rescataba lo esencial de la vida y el trabajo de Sophie Germain (1776-1831) en su hermosa semblanza Mudanza de nombre. El escritor uruguayo escribía sobre la matemática y la Torre Eiffel en estos términos:
[…] Sophie fue la única mujer aceptada en el masculino Olimpo de la ciencia europea: en las matemáticas, profundizando teoremas, y después en la física, donde revolucionó el estudio de las superficies elásticas.
Un siglo después, sus aportes contribuyeron a hacer posible, entre otras cosas, la torre Eiffel.
La torre lleva grabados los nombres de varios científicos.
Sophie no está. […]
En efecto, la Torre Eiffel tiene grabados en los pretiles de la primera línea de balcones 72 nombres de científicos e ingenieros franceses destacados por sus contribuciones. Fue Gustave Eiffel quien eligió los nombres de esos eruditos –todos varones–: cada fachada de la torre (Trocadero, Escuela Militar, Grenelle y París) contiene 18 apellidos.
 Sophie Germain y la Torre Eiffel. Fuentes: Wikimedia Commos
Sophie Germain y la Torre Eiffel. Fuentes: Wikimedia Commos
El pasado día 26 de enero, la alcaldesa de París, Anne Hidalgo, dio a conocer la propuesta de 72 científicas cuyos nombres se inscribirán en la Torre Eiffel como reconocimiento a la importancia de sus aportaciones científicas.
Esta iniciativa, que comenzó a fraguarse en el primer trimestre de 2025, ha sido liderada por la ciudad de París, la Sociedad de Explotación de la Torre Eiffel (SETE) y la asociación Femmes & Sciences. Una comisión de personas expertas, presidida por la astrofísica Isabelle Vauglin y Jean-François Martins, presidente de la SETE, han colaborado para seleccionar estos 72 nombres. Además, proponen que se coloquen en un friso (sobre el que ya existe) en la primera planta de la torre. Este listado de 72 nombres se enviará a las tres academias competentes (Ciencias, Medicina y Tecnologías) que validarán oficial y definitivamente esta propuesta.
Las matemáticas de la lista
Diez de los nombres corresponden a matemáticas francesas. Por supuesto, una de ellas es Sophie Germain. Presentamos una breve reseña de cada una de ellas.
- Yvette Amice (1936-1993) centró su investigación en teoría de númerosy análisis p-ádico. Fue la segunda mujer que presidió la Société Mathématique de France (1975), tras Marie-Louise Dubreil-Jacotin (1952).
- Yvonne Choquet-Bruhat (1923-2025) fue la primera mujer en ser elegida miembro de la Académie des sciences, fue en 1979. Estableció los primeros resultados rigurosos sobre las ecuaciones de Einstein, abriendo la vía de estudio matemático del espacio-tiempo.
- Marie-Louise Dubreil-Jacotin (1905-1972) comenzó a trabajar en álgebra tras conocer a Emmy Noether. Junto a su marido, Paul Dubreil, publicó Leçons d’algèbre moderne, libro de gran difusión en esta área.
- Jacqueline Ferrand (1918-2014) trabajó fundamentalmente en análisis real y complejo y geometría diferencial. Entre sus muchas publicaciones y manuales universitarios, destacan los cuatro tomos de Cours de Mathématiquesjunto a Jean-Marie Arnaudiès.
- Sophie Germain (1776-1831) realizó importantes contribuciones a la teoría de números; uno de los más importantes fue el estudio de los que se denominan números primos de Germain. Fue la primera mujer en ganar un premio de la Académie des sciences (1815) por su disertación sobre superficies elásticas, que sentó las bases para la investigación sobre la resistencia de los materiales, en particular para la construcción de la Torre Eiffel.
- Geneviève Guitel (1895-1982) introdujo los términos escala largay escala corta (en Histoire comparée des numérations écrites, 1975) para referirse a dos de los principales sistemas de numeración utilizados en el mundo.
- Paulette Libermann (1919-2007) fue especialista en geometría diferencial y geometría simpléctica, centrándose en la teoría de jets, entre otros.
- Edith Mourier (1920-2017) fue especialista en teoría de probabilidad. En 1954 defendió su tesis, Éléments aléatoires dans un espace de Banach, en la que generaliza la ley de los grandes números relativa a puntos aleatorios de espacios de Banach: es el teorema de Fortet-Mourier, que se utiliza para cuantificar la diferencia entre dos medidas.
- Michelle Schatzman (1949-2010) fue especialista en matemática aplicada, a la que contribuyó con más de 70 artículos. Trabajó fundamentalmente en análisis no linealy análisis numérico.
- Marie-Hélène Schwartz (1913-2013) es conocida por sus trabajos sobre clases característicasasociadas a espacios con singularidades.
Bonus
Debajo aparece el listado (por orden alfabético de apellido) de las 72 científicas francesas (o que realizaron su investigación en Francia) propuestas para que sus nombres se inscriban en la Torre Eiffel. Las diez matemáticas están marcadas en negrita.
- Denise Albe-Fessard (1916-2003), neurofisióloga
- Yvette Amice (1936-1993), matemática
- Jeanne Baret (1740-1807), botánica y exploradora
- Denise Barthomeuf (1934-2004), química de materiales
- Madeleine Brès (1842-1921), médica
- Simonne Caillère (1905-1999), geóloga y mineralogista
- Yvette Cauchois (1908-1999), química física
- Edmée Chandon (1885-1944), astrónoma
- Yvonne Choquet-Bruhat (1923-2025), física y matemática
- Marthe Condat (1886-1939), médica
- Anita Conti (1899-1997), oceanógrafa
- Eugenie Cotton (1881-1967), física
- Radhia Cousot (1947-2014), informática
- Odile Croissant (1923-2020), física y bióloga
- Marie Curie (1867-1934), física
- Augusta Dejerine-Klumpke (1859-1927), neuróloga
- Henriette Delamarre de Monchaux (1854-1911), geóloga y paleontóloga
- Georgette Délibrias (1924-2015), física
- Nathalie Demassieux (1884-1961), química
- Rose Dieng (1956-2008), informática
- Angélique du Coudray (1712-1794), obstetra
- Louise du Pierry (1746-1830), astrónoma
- Marie-Louise Dubreil-Jacotin (1905-1972), matemática
- Jacqueline Ferrand (1918-2014), matemática
- Jacqueline Ficini (1923-1988), química
- Rosalind Franklin (1920-1958), química física
- Marthe Gautier (1925-2022), bióloga médica
- Sophie Germain (1776-1831), matemática
- Marianne Grunberg-Manago (1921-2013), bioquímica
- Jeanne Guiot (1889-1963), ingeniera
- Geneviève Guitel (1895-1982), matemática
- Sébastienne Guyot (1896-1941), ingeniera aeronáutica
- Claudine Hermann (1945-2021), física
- Andrée Hoppilliard (1909-1995), ingeniera aeronáutica
- Irène Joliot-Curie (1897-1956), química
- Geneviève Jourdain (1946-2007), ingeniera informática
- Dorothea Klumpke (1861-1942), astrónoma
- Lydie Koch (1931-2023), física
- Colette Kréder (1934-2022), ingeniera
- Nicole Laroche (1945-2019), ingeniera en Artes y Oficios
- Cornélie Lebon-de Brambilla (1767-1812), ingeniera
- Yolande Le Calvez (1910-2002), geóloga y paleontóloga
- Paulette Libermann (1919-2007), matemática
- Nicole Mangin (1878-1919), médica
- Henriette Mathieu-Faraggi (1915-1985), física
- Cécile Morette (1922-2017), física
- Edith Mourier (1920-2017), matemática
- Ethel Moustacchi (1933-2016), bioquímica
- Suzanne Noël (1878-1954), cirujana
- Yvonne Odic (1890-1982), ingeniera mecánica
- Isabelle Olivieri (1957-2016), ingeniera agrónoma y bióloga
- Marie-Louise Paris (1889-1969), ingeniera
- Marguerite Perey (1909-1975), radioquímica
- Claudine Picardet (1735-1820), química
- Alberte Pullman (1920-2011), química
- Pauline Ramart (1880-1953), química
- Lucie Randoin (1885-1960), química nutricional
- Alice Recoque (1929-2021), ingeniera informática
- Michelle Schatzman (1949-2010), matemática
- Anne-Marcelle Schrameck (1896-1965), ingeniera química
- Marie-Hélène Schwartz (1913-2013), matemática
- Josiane Serre (1922-2004), química
- Alice Sollier (1861-1942), psiquiatra
- Helène Sparrow (1891-1970), bióloga y médica
- Bianca Tchoubar (1910-1990), química
- Marie Antoinette Tonnelat (1912-1980), física teórica
- Thérèse Tréfouël (1892-1978), química
- Agnès Ullmann (1927-2019), bióloga molecular
- Arlette Vassy (1913-2000), física atmosférica
- Suzanne Veil (1886-1956), ingeniera química
- Jeanne Villepreux-Power (1794-1871), naturalista
- Toshiko Yuasa (1909-1980), física teórica
Referencias
- 72 femmes de sciences pour la tour Eiffel, MkF
- Marta Macho Stadler, 72 científicas para la Torre Eiffel, Mujeres con ciencia, Hitos, 10 febrero 2026
Sobre la autora: Marta Macho Stadler es profesora de Topología en el Departamento de Matemáticas de la EHU y editora de Mujeres con Ciencia
El artículo Las diez matemáticas de la Torre Eiffel se ha escrito en Cuaderno de Cultura Científica.
Zoriz aurkitu den antibiotiko batek bakterio superresistentei aurre egiteko balio lezake
Antibiotikoekiko erresistentzia garatzen duten bakterioak osasun-arazo bihurtu dira, eta etorkizuneko mehatxu garrantzitsuenetariko bat direla esan genezake. Osasunaren Mundu Erakundearen arabera, 2050erako baliteke urtero hamar milioi pertsona hiltzea antibiotikoekiko erresistenteak diren bakterioek kutsatuta. Hori ekiditeko, oinarrizko helburutzat hartzen dira antibiotikoen erabilera zuzenagoa eta bakterio superresistenteen kontrako antibiotiko berriak sortzea. Oraingoan, Erresuma Batuko Warwick-eko Unibertsitatean egindako aurkikuntza batek sortu du itxaropena bakterio superresistentei aurre egiteko borrokan.
Botika berrien aurkikuntzan sarri egon dira zorizko gertaerak. Beharbada, entzutetsuena Albert Flemingek esperimentuak egiteko zituen mikroorganismo-plaketariko bat Penicillium onddoak kutsatu zuenekoa da. Itxura denez, Fleming doktoreak jai egun batzuk hartu zituen, eta, bueltatu zenean, bakterioak zituen plaketariko bat onddo batek kutsatuta zegoen, eta onddoa zegoen inguruan ez zen bakteriorik hazten. Abiapuntu hori izan zuen gizateriaren historiako aurkikuntza farmazeutiko garrantzitsuenetarikoak, eta, ondorioz, Flemingek Medikuntzako Nobel saria jaso zuen 1945. urtean. Antzerako zerbait gertatu zen Hans Peter Frey biologoak ziklosporina aurkitzen lagundu zuenean. Freyk enpresa farmazeutiko suitzar batean lan egiten zuen; oporretan Norvegian zela, lurreko lagin batzuk jaso zituen eta lan egiten zuen konpainiaren laborategietara eraman zituen. Lagin haietatik ziklosporina isolatzea lortu zen, eta, gaur egun, immunoezabatzaile moduan erabiltzen da, batez ere bihotzeko transplanteak egin ondoren errefusa saihesteko.
 Irudia: antibiotikoekiko erresistenteak diren bakterio patogeno Gram-positiboen aurkako jarduera areagotzea. (Argazkia: J. Am. Chem. Soc. 2025, 147, 44, 40554-40561)
Irudia: antibiotikoekiko erresistenteak diren bakterio patogeno Gram-positiboen aurkako jarduera areagotzea. (Argazkia: J. Am. Chem. Soc. 2025, 147, 44, 40554-40561)Oraingo honetan, zorizko aurkikuntzari premetilenomizina C laktona deritzo, Streptomyces coelicolor bakterioak sortzen duen metilenomizina A antibiotikoaren bitartekari bat. S. coelicolor lurzoruan dagoen bakterio bat da; 1965. urtean zientzialariek ikusi zuten metilenomizina A antibiotikoa sortzeko gai zela, eta antibiotiko hori erabilgarria zela hainbat mikroorganismo patogenoren aurka. Azken urteotan, Warwickeko Unibertsitateko ikertzaile talde batek, Gregory Challis doktorearen gidaritzapean, metilenomizina A-ren ekoizpenean sakondu du, eta, horretarako, S. coelicolor bakterioaren hainbat gene manipulatu dituzte. Ekoizpen-prozesua sakon aztertzean, ikertzaileek ikusi dute metilenomizina A sortu aurretik premetilenomizina C laktona konposatua sortzen dela bitartekari moduan; baina prozesu kimikoa hain da azkarra, ezen naturalki gertatzen denean bigarren horren aztarnarik ez baita gelditzen.
Geneak manipulatzean, prozesua premetilenomizina C laktonaren ekoizpenean gelditzea lortu zuten 2017. urtean, Challisen laborategian doktorego-tesia egiten ari zen ikertzaile bati bururatu zitzaion bitartekari horren gaitasun antimikrobianoa neurtzea. Ezustekoa itzela izan zen. Premetilenomizina C laktona gai zen mililitroko mikrogramo bakar batekin Staphylococcus aureus andui erresistenteak hiltzeko; metilenomizina A-k, berriz, 256 mikrogramo mililitroko kontzentrazioan egiten zuen. Erresistentzia neurtzean ere emaitza positiboak lortu zituzten. Gernu-infekzio larriak sortzen dituen Enterococcus faecium bakterioa 28 egunetan kontaktuan jarri zuten, dosi txikitan, vanomizinarekin eta premetilenomizina C laktonarekin. Vanomizinarekin tratatzean, 28 egun pasatu ondoren E. faeciumek erresistentzia garatzen zuen, eta, behin erresistente bihurtuta, berau hiltzeko 8 aldiz kontzentrazio handiagoa erabili behar zen; aldiz, premetilenomizina C laktonarekin, 28 egun igaro ondoren, ez zen garatzen erresistentziarik, eta E. faecium hiltzeko gutxieneko kontzentrazioa berdina zen. 2025. urtean lortu da premetilenomizina C laktona modu industrialean sortzea, eta laster klinikan erabilgarri izatea espero da.
Flemingen, Freyren edo Challisen ikertaldeko ikertzaileek egin zituzten aurkikuntzetan zortea giltzarri izan zela esan dezakegu. Nik uste dut, ordea, guztiek beste osagai bat dutela amankomunean: jakin-mina. Ikertzailearen sen moduan ere ezaguna den jakin-min horrek eraman zituen guztiak ere aukera berriak bilatzera.
Erreferentzia bibliografikoak:- Bryson, Bill (2019). The Body: A Guide for Occupants.Doubleday. ISBN: 0385539304.
- Corre, Christophe; Idowu, Gideon A.; Song, Lijiang; Whitehead, Melanie E.; Alkhalaf, Lona M.; Challis, Gregory L. (2025). Discovery of Late Intermediates in Methylenomycin Biosynthesis Active against Drug-Resistant Gram-Positive Bacterial Pathogens. Journal of the American Chemical Society, 147,44. DOI: 10.1021/jacs.5c12501
Iker Badiola Etxaburu (@ikerbadiola.bsky.social) EHUko Medikuntza eta Erizaintza Fakultateko irakaslea eta EHUko Kultura Zientifikoko Katedrako zuzendaria da.
The post Zoriz aurkitu den antibiotiko batek bakterio superresistentei aurre egiteko balio lezake appeared first on Zientzia Kaiera.
Una demostración muy buscada para domar algunas de las ecuaciones más rebeldes de las matemáticas
Los matemáticos comprenden finalmente el comportamiento de una importante clase de ecuaciones diferenciales que describen todo, desde la presión del agua hasta los niveles de oxígeno en los tejidos humanos.
Un artículo de Paulina Rowińska. Historia original reimpresa con permiso de Quanta Magazine, una publicación editorialmente independiente respaldada por la Fundación Simons.
 Para estudiar el flujo de aire alrededor del ala de un avión, la distribución de los esfuerzos en un puente u otras situaciones muy diversas, los investigadores utilizan ecuaciones diferenciales parciales elípticas. Estas ecuaciones son notoriamente difíciles de comprender. Ilustración: Kristina Armitage; Michael Kanyongolo /Quanta Magazine
Para estudiar el flujo de aire alrededor del ala de un avión, la distribución de los esfuerzos en un puente u otras situaciones muy diversas, los investigadores utilizan ecuaciones diferenciales parciales elípticas. Estas ecuaciones son notoriamente difíciles de comprender. Ilustración: Kristina Armitage; Michael Kanyongolo /Quanta MagazineLa trayectoria de una tormenta, la evolución de los precios de las acciones, la propagación de una enfermedad: los matemáticos pueden describir cualquier fenómeno que cambie en el tiempo o en el espacio mediante lo que se conoce como ecuaciones diferenciales parciales. Pero hay un problema: estas «EDP» suelen ser tan complicadas que resulta imposible resolverlas directamente.
En su lugar, los matemáticos recurren a un ingenioso rodeo. Puede que no sepan calcular la solución exacta de una ecuación dada, pero pueden intentar demostrar que dicha solución debe ser «regular», o bien comportada en cierto sentido; por ejemplo, que sus valores no den saltos repentinos físicamente imposibles. Si una solución es regular, los matemáticos pueden utilizar diversas herramientas para aproximarla y así comprender mejor el fenómeno que quieren estudiar.
Sin embargo, muchas de las EDP que describen situaciones realistas han permanecido fuera de alcance. Los matemáticos no han logrado demostrar que sus soluciones sean regulares. En particular, algunas de estas ecuaciones inalcanzables pertenecen a una clase especial de EDP para la que los investigadores desarrollaron durante un siglo toda una teoría, una teoría que nadie consiguió hacer funcionar para esta subclase concreta. Se toparon con un muro.
Ahora, dos matemáticos italianos han logrado por fin romper esa barrera, ampliando la teoría para abarcar esas EDP más desordenadas. Su artículo, publicado el verano pasado, marca la culminación de un ambicioso proyecto que, por primera vez, permitirá a los científicos describir fenómenos reales que durante mucho tiempo han desafiado el análisis matemático.
Traviesas o buenas
Durante una erupción volcánica, un río abrasador y caótico de lava fluye sobre el terreno. Pero al cabo de horas o días (o quizá incluso más tiempo), se enfría lo suficiente como para entrar en un estado de equilibrio. Su temperatura deja de cambiar de un momento a otro, aunque sigue variando de un lugar a otro en la vasta extensión de espacio que cubre la lava.
 Los matemáticos modelan sistemas que cambian en el espacio, pero no en el tiempo —la temperatura de un flujo de lava en equilibrio, la distribución de nutrientes en los tejidos, la forma de una película de jabón— mediante ecuaciones diferenciales parciales elípticas.
Los matemáticos modelan sistemas que cambian en el espacio, pero no en el tiempo —la temperatura de un flujo de lava en equilibrio, la distribución de nutrientes en los tejidos, la forma de una película de jabón— mediante ecuaciones diferenciales parciales elípticas.Fuentes, de arriba a abajo: Giles Laurent/Creative Commons; Mikael Häggström/Creative Commons; Ted Kinsman/Science Source
Los matemáticos describen situaciones como esta mediante lo que se llaman EDP elípticas. Estas ecuaciones representan fenómenos que varían en el espacio pero no en el tiempo, como la presión del agua que fluye a través de una roca, la distribución de tensiones en un puente o la difusión de nutrientes en un tumor.
Pero las soluciones de las EDP elípticas son complicadas. La solución de la EDP de la lava, por ejemplo, describe su temperatura en cada punto, dadas unas condiciones iniciales. Depende de muchas variables que interactúan entre sí.
Los investigadores quieren aproximar esa solución incluso cuando es imposible escribirla de forma explícita. Pero los métodos que utilizan solo funcionan bien si la solución es regular, es decir, si no presenta saltos ni quiebros bruscos (no habrá picos afilados en la temperatura de la lava de un lugar a otro). «Si algo falla, probablemente se deba a la [falta de] regularidad», explica Makson Santos, de la Universidad de Lisboa.
En la década de 1930, el matemático polaco Juliusz Schauder trató de establecer las condiciones mínimas que debe satisfacer una EDP elíptica para garantizar que sus soluciones sean regulares. Demostró que, en muchos casos, basta con probar que las reglas incorporadas en la ecuación —como la regla que describe la rapidez con la que se propaga el calor en la lava— no cambian de forma demasiado abrupta de un punto a otro.
En las décadas transcurridas desde la demostración de Schauder, los matemáticos han mostrado que esta condición es suficiente para asegurar que cualquier EDP que describa un material «agradable» y uniforme tiene soluciones regulares. En un material así, existe un límite a lo extremas que pueden ser las reglas subyacentes. Por ejemplo, si se supone que la lava es uniforme, el calor siempre fluirá dentro de ciertos límites de velocidad, nunca demasiado rápido ni demasiado lento.
Pero la lava es en realidad una mezcla diversa de roca fundida, gases disueltos y cristales. En un material no uniforme como este, no se pueden controlar los extremos, y pueden aparecer diferencias más drásticas en la rapidez con la que se propaga el calor según el lugar: algunas regiones de la lava pueden conducir el calor extremadamente bien y otras extremadamente mal. En este caso, se utiliza una EDP «no uniformemente elíptica» para describir la situación.
Durante décadas, nadie pudo demostrar que la teoría de Schauder siguiera siendo válida para este tipo de EDP.
Por desgracia, «el mundo real es no uniformemente elíptico», explica Giuseppe Mingione, matemático de la Universidad de Parma, en Italia. Eso significaba que los matemáticos estaban atascados. Mingione quería entender por qué.
Máquina del tiempo
En agosto de 2000, Mingione —con 28 años y recién doctorado— se encontraba en un viejo balneario en ruinas de Rusia, asistiendo a un congreso sobre ecuaciones diferenciales. Una noche, sin nada mejor que hacer, empezó a leer artículos de Vasiliĭ Vasil’evich Zhikov, un matemático al que había conocido en el viaje, y se dio cuenta de que las EDP no uniformemente elípticas que parecen bien comportadas pueden tener soluciones irregulares incluso cuando satisfacen la condición identificada por Schauder. La teoría de Schauder no era simplemente más difícil de demostrar en el caso no uniforme: necesitaba una actualización.
 Giuseppe Mingione ha ayudado a probar una conjetura que formuló hace 20 años. La prueba final, según él, fue «un milagro por desesperación». Foto: Giampiero Palatucci
Giuseppe Mingione ha ayudado a probar una conjetura que formuló hace 20 años. La prueba final, según él, fue «un milagro por desesperación». Foto: Giampiero PalatucciDe vuelta en Italia, se unió a dos colegas y propuso que las EDP no uniformemente elípticas debían satisfacer una condición adicional para garantizar que sus soluciones fueran regulares. No solo las reglas que gobiernan el flujo de calor tenían que cambiar gradualmente de un punto a otro, sino que esos cambios debían estar estrictamente controlados para tener en cuenta la no uniformidad de la lava. En particular, sostenían los matemáticos, cuanto más desigual sea el material, más estricto debe ser ese control. Representaron esta condición mediante una desigualdad, que daba un umbral preciso de cuánta no uniformidad podía tolerar un sistema.
Mostraron que, para las EDP en las que la desigualdad no se cumple, ya no se puede garantizar que las soluciones sean regulares. Pero no pudieron demostrar que la desigualdad marque exactamente el punto en el que las soluciones pasan de ser regulares a potencialmente irregulares. Mingione pasó años trabajando en el problema, sin éxito. Finalmente, abandonó el intento.
Pasaron casi 20 años. Entonces, en 2017, una estudiante de primer año de doctorado llamada Cristiana De Filippis oyó hablar de la búsqueda de una extensión de la teoría de Schauder a ecuaciones no uniformemente elípticas. Matemáticos con más experiencia le advirtieron que no se metiera en ese problema, pero ella ignoró el consejo y se puso en contacto con Mingione. En una llamada nocturna por Skype, le dijo que tenía algunas ideas sobre cómo demostrar su conjetura y que estaba decidida a retomar el trabajo donde él lo había dejado.
 Cristiana De Filippis ha estado desarrollando una teoría amplia para comprender mejor las soluciones de ecuaciones diferenciales parciales, centrándose en casos cada vez más complejos. Foto: Giampiero Palatucci
Cristiana De Filippis ha estado desarrollando una teoría amplia para comprender mejor las soluciones de ecuaciones diferenciales parciales, centrándose en casos cada vez más complejos. Foto: Giampiero Palatucci«Fue como una máquina del tiempo», cuenta Mingione. «Fue como encontrarme conmigo mismo de hace 20 años llamando a la puerta de mi propia mente».
Según él, fue la «nueva energía, el entusiasmo y la fe en que esto se podía hacer» de De Filippis lo que le convenció de reactivar su intento, largamente dormido, de demostrar su conjetura.
Milagros
La clave para demostrar que la solución de una EDP es regular consiste en mostrar que siempre cambia de manera controlada. Los matemáticos lo hacen estudiando una función especial que describe con qué rapidez cambia la solución en cada punto. Quieren demostrar que esta función, llamada gradiente, no puede hacerse demasiado grande.
Pero, del mismo modo que suele ser imposible calcular directamente la solución de una EDP, también suele ser imposible calcular su gradiente.
 El matemático polaco Juliusz Schauder se propuso comprender cuándo los modelos de sistemas físicos ofrecen una imagen precisa de la realidad y cuándo no. Fuente: Dominio público
El matemático polaco Juliusz Schauder se propuso comprender cuándo los modelos de sistemas físicos ofrecen una imagen precisa de la realidad y cuándo no. Fuente: Dominio públicoEn su lugar, De Filippis y Mingione dedujeron de la EDP original lo que llamaron una «ecuación fantasma», una sombra de aquello que realmente necesitaban.
Ahí es donde Mingione se había quedado atascado décadas antes. Pero De Filippis tuvo una idea para afinar la ecuación fantasma de modo que ofreciera una visión más nítida de la EDP. Mediante un procedimiento largo y de muchos pasos, la pareja consiguió extraer de la ecuación fantasma información suficiente para reconstruir el gradiente.
«Es un poco rebuscado hacerlo así», comenta Simon Nowak, de la Universidad de Bielefeld, en Alemania. «Pero funciona, y es bastante bonito».
Ahora tenían que averiguar cómo demostrar que el gradiente recuperado no podía hacerse demasiado grande. Lo descompusieron en piezas más pequeñas y demostraron que cada una de ellas no podía superar un tamaño determinado. Esto requirió un esfuerzo enorme: incluso un diminuto error de medida en una sola pieza arruinaría su estimación del gradiente y los alejaría del umbral que pretendían demostrar.
En un preprint de 2022, lograron controlar todas esas piezas lo suficiente como para demostrar que la mayoría de las EDP no uniformemente elípticas que satisfacen la desigualdad de Mingione deben tener soluciones regulares. Pero todavía faltaban algunas EDP. Para demostrar la conjetura completa, los matemáticos tuvieron que obtener cotas aún mejores para el tamaño de las piezas del gradiente. No había absolutamente ningún margen de maniobra. Eso obligó a empezar de nuevo muchas veces: «un juego interminable», dice De Filippis. Pero, al final, consiguieron demostrar que el umbral que Mingione había previsto décadas atrás era exactamente el correcto.
Fue «un milagro por desesperación», afirma él.
De Filippis y Mingione no solo han completado un proyecto de un siglo de duración. También han hecho posible que los matemáticos estudien procesos reales complejos que hasta ahora tenían que modelizarse mediante ecuaciones irrealmente simplificadas.
Los investigadores también están entusiasmados por aplicar sus técnicas al estudio de otros tipos de ecuaciones diferenciales parciales, incluidas las que cambian tanto en el espacio como en el tiempo. «La parte mágica es que estaban reuniendo toda esta teoría profunda bajo un mismo paraguas y luego extrayendo de ahí la demostración», comenta Tuomo Kuusi, de la Universidad de Helsinki.
Las EDP siempre han sido casi prohibitivamente difíciles de analizar desde el punto de vista matemático. Ahora lo son un poco menos. Detrás de ellas, dice De Filippis, «hay una enorme realidad» esperando ser explicada.
El artículo original, Long-Sought Proof Tames Some of Math’s Unruliest Equations, se publicó el 8 de diciembre de 2025 en Quanta Magazine.
Traducido por César Tomé López
El artículo Una demostración muy buscada para domar algunas de las ecuaciones más rebeldes de las matemáticas se ha escrito en Cuaderno de Cultura Científica.
Probiotikoen erabilgarritasuna obesitatearen tratamendurako
Obesitatea gaixotasun metaboliko kronikoa da, osasunean eragin negatiboak sortzen dituen gehiegizko gantz-ehunaren metaketak ezaugarritzen duena. Nahiz eta obesitatearen garapena denboran mantentzen den energia-balantze positibo baten ondorioa izan, errealitateak erakusten du gaixotasun hori askoz ere konplexuagoa dela.
Izan ere, hainbat faktore etiologiko identifikatu dira obesitatearen garapenean eragina dutenak. Horien artean, gero eta arreta handiagoa berenganatu dute hesteko mikrobiotaren asaldurek (disbiosi izena ematen zaie). Izatez, ikerketa ezberdinek erakutsi dute pertsona obesoen hesteko mikrobiotaren osaera pertsona osasuntsuek dutenaren ezberdina dela.
Testuinguru honetan, abian dira hainbat ikerlan, aztertzeko ea obesitatearen tratamendurako estrategia lagungarria izan daitekeen pertsona obesoen hesteko mikrobiotaren osaera moldatzea (mikrobiota osasuntsu bat lortzeko).
Hesteko «mikrobiota obesoak» dituen inplikazioak osasuneanHesteko mikrobiota mikroorganismo-komunitate (nagusiki, bakterioak) konplexua da, ostalariaren (gure) osasunerako garrantzitsuak diren funtzio ezberdinak erregulatzen dituena. Funtzio horien artean daude, besteak beste, nutrienteen digestio, xurgapena eta metabolismoa, edota erantzun immunearen erregulazioa1.
Hori gertatzeko, ordea, ezinbestekoa da mikrobiotaren osaera osasuntsua izatea (eubiosi gisa ezagutzen dena). Nahiz eta mikrobiotaren «osaera estandarrik» ez den existitzen (hainbat faktoreren menpe dagoelako), oro har, osasuntsutzat jo liteke mikroorganismo-aberastasun handia, hesteko hesi-funtzio egokia eta hanturaren aurkako efektua duten metabolitoak ekoizten dituen mikrobiota. Aitzitik, obesitatea duten pertsonen mikrobiotak ezaugarri hauek lituzke; aberastasun txikiagoa, bitartekari hantura-eragileen ekoizpen handitua eta hesteko hesi-funtzioaren galera (1. irudia).
 Irudia: obesitatea duten banakoen hesteko mikrobiotaren ezaugarriak. F/B: Firmicutes/Bacteroidetes ratioa, KLGA: kate laburreko gantz-azidoak, LPS: lipopolisakaridoa.Probiotikoak eta obesitatea: zer dira eta nola funtzionatzen dute
Irudia: obesitatea duten banakoen hesteko mikrobiotaren ezaugarriak. F/B: Firmicutes/Bacteroidetes ratioa, KLGA: kate laburreko gantz-azidoak, LPS: lipopolisakaridoa.Probiotikoak eta obesitatea: zer dira eta nola funtzionatzen dute
Definizioz, probiotikoak, kantitate egokian hartuta, osasunerako efektu onuragarriak dituzten mikroorganismoak dira2. Nahiz eta probiotikoen erabilpena nagusiki asaldura gastrointestinalen kudeaketara bideratzen den, baliagarriak izan daitezke obesitatearen tratamendurako ere.
Izatez, ikusi da probiotikoen kontsumoak (bakterio-andui bakarra edo nahasketak) gorputz-pisuaren, gorputzeko gantz-edukiaren edo/eta gerri-perimetroaren murrizketa esanguratsuak eragiten dituela obesitatea duten pertsonetan3.
Efektu horiek bideratzen dituzten ekintza-mekanismoak guztiz ezagutzen ez diren arren, hainbat ikerlanek azpimarratzen dute probiotikoen kontsumoak eragiten duen hesteko mikrobiotaren modulazioa. Horren ondorioz, mikrobiotaren osaera egokia faboratzen da, hanturaren aurkako bitartekariak ekoiztuko baititu (kate laburreko gantz azidoak, nagusiki)3.
Bestalde, hainbat ikerlanek erakutsi dute probiotikoen kontsumoak eragina duela janguraren erregulazioan ere. Efektu hori probiotikoek heste-garun ardatzean duten eraginak azaltzen du. Horrela, animalietan egindako ikerlanek erakutsi dute probiotikoen administrazioak asetasun-hormonen (hala nola YY peptidoa, glukagoiaren antzeko 1 peptidoa eta kolezistokinina) gene-adierazpena handitzen dutela kolonean, hipotalamoko neurona anorexigenikoen (jangura murrizten dutenak) gene-adierazpena handitzearekin batera (propiomelanokortinak eta kokainak eta anfetaminak erregulatutako transkriptoa, besteak beste)4.
Era berean, ikusi da probiotikoen administrazioak eragindako hesteko mikrobiotaren modulaziotik eratorritako kate laburreko gantz azidoek zeresana dutela janguraren erregulazioan. Horrela, probiotikoen administrazioak butirato-ekoizpena handitzen duela frogatu da, zeinak glukagoiaren antzeko 1 peptidoa hormonaren sintesian eta jarioan parte hartzen duten geneen adierazpena kitzikatzen baitu4.
Azkenik, aipatzekoa da, baita ere, probiotikoen administrazioa odoleko grelina-mailaren normalizazioarekin lotzen dela, zeina handiagotuta egoten baita pertsona obesoetan5. Kontuan izanik grelinak jangura handitzen duela, obesitatearen tratamendurako beste estrategia bat izan daiteke haren mailak balio normaletara murriztea5.
Probiotikoen erabilpenak dituen mugak eta alternatiba posibleakEbidentzia zientifikoak probiotikoak obesitatearen tratamenduan erabilgarriak izan daitezkeela erakusten duen arren, badituzte zenbait muga. Muga nagusia hau da: probiotikoak hartzeak inplikatzen du bizirik dauden bakterioak irensten ari garela. Horrek infekzio sistemikoak pairatzeko edota hesterako translokazio bakterianoa garatzeko arriskua dakar, bereziki gaixo dauden pertsonek hartzen badituzte6.
Ondorioz, inaktibatutako probiotikoak erabiltzea proposatu da alternatiba gisa. Izan ere, ikerlan ezberdinek erakutsi dute bakterio probiotikoak bizirik egotea ez dela ezinbestekoa osasunean efektu onuragarriak izan ditzaten. Horrela, ikusi da probiotikoen onurak bakterioek dituzten osagaiek eragiten dituztela (peptidoglikanoak, azido teikoikoak edota gainazal-proteinak, besteak beste), eta ez bakterioek hestea kolonizatzeak (uste zen bezala).
Izatez, bakterioen inaktibazio-prozesuak (beroa, presioa edo/eta ultrasoinuak aplikatuz), konposatu bioaktibo horien eskuragarritasuna handitu dezake. Horrek azalduko luke, hein handi batean, inaktibatutako probiotikoak jatorrizko probiotiko biziak baino eraginkorragoak izatea sarritan.
Nahiz eta inaktibatutako probiotikoen inguruko ebidentzia mugatua izan, argitaratutako hainbat lanek frogatu dute euren eraginkortasuna. Obesitatearen kasuan, animaliekin zein gizakiekin egindako ikerlanek erakutsi dute inaktibatutako probiotikoek gorputz-pisua eta gantz-masa murrizten lagundu dezaketela7.
Nabarmendu behar da, gainera, inaktibatutako probiotikoak eraginkorrak direla obesitatearekin lotzen diren osasun-asalduren (gibel-esteatosia eta intsulinarekiko erresistentzia) kudeaketan ere7. Hori jakinik, orain, erronka nagusia izango da konposatu bakteriano eraginkorrenak identifikatu eta horietan oinarritzen diren tratamendu pertsonalizatu eta efizienteak garatzea.
Laburbilduz, eskuragarri dagoen ebidentzia zientifikoak erakusten du probiotikoak tresna baliagarriak izan daitezkeela obesitatearen tratamendurako. Probiotikoek obesitatean dituzten efektu onuragarriak, nagusiki, hesteko mikrobiota egokia berreskuratzeak eta heste-garun ardatzaren erregulazioak bideratzen dituzte. Azken urteetan egindako ikerketen arabera, probiotikoek ez dute bizirik egon behar aipatutako onurak lortzeko. Horrek, berriz, tratamendu seguru eta eraginkorragoak garatzen lagundu dezake.
Erreferentzia bibliografikoa:- [1] Peluzio, Maria do Carmo Gouveia; Martinez, J. Alfredo; Milagro, Fermin I. (2021). Postbiotics: Metabolites and mechanisms involved in microbiota-host interactions. Trends in Food Science & Technology, 108, 11-26. DOI: 0.1016/j.tifs.2020.12.004
- [2] Vandenplas, Yvan; Huys, Geert; Daube, Georges. (2015). Probiotics: An update. J. Pediatr. (Rio J.), 91, 6–21. DOI: 10.1016/j.jped.2014.08.005
- [3] Wiciński, Michał; Gębalski, Jakub; Gołębiewski, Jakub; Malinowski, Bartos (2020). Probiotics for the Treatment of Overweight and Obesity in Humans-A Review of Clinical Trials. Microorganisms, 8(8), 1148. DOI: 10.3390/microorganisms8081148
- [4] Yadav, Hariom; Lee, Ji-Hyeon; Lloyd, John; Walter, Peter; Rane, Sushil G. (2013). Beneficial metabolic effects of a probiotic via butyrate-induced GLP-1 hormone secretion. Journal of Biological Chemistry, 288, 25088–2597. DOI: 10.1074/jbc.M113.452516
- [5] Schellekens, Harriët; Torres-Fuente, Cristina; van de Wouw, Marcel; Long-Smith, Caitriona M.; Mitchel, Avery; Strai, Conall; Berding, Kirsten; Bastiaanssen, Thomaz F. S.; Re, Kieran; Golubeva, Anna V.; Arboleya, Silvia; Verpaalen, Mathieu; Pusceddu, Matteo M.; Murphy, Amy; Fouhy, Fiona; Murphy, Kiera; Ross, Paul; Roy, Bernard L.; Stanton, Catherine; Dinan, Timothy G.; Cryan, John F. (2021). Bifidobacterium longum counters the effects of obesity: Partial successful translation from rodent to human. EBioMedicine, 63, 103176. DOI: 10.1016/j.ebiom.2020.103176
- [6] Doron, Shira; Snydman, David (2015). Risk and safety of probiotics. Clinical Infectious Diseases, 60(S2), S129-134. DOI: 10.1093/cid/civ085
- [7] Arellano-García, LAura Isabel; Portillo, María P.; Martínez, J. Alfredo; Courtois, Arnaud; Milton-Laskibar, Ikañi. (2025). Postbiotics for the management of obesity, insulin resistance/type 2 diabetes and NAFLD. Beyond microbial viability. Critical Reviews in Food Science and Nutrition, 65(29), 6209–6232. DOI: 10.1080/10408398.2024.2437143
Laura Arellano-García, Saioa Gómez-Zorita, María Puy Portillo eta Iñaki Milton-Laskíbar EHUko Farmazia Kafultateko Farmazia eta Elikagaien Zientziak Saileko eta CIBEROBN Obesitatearen Fisiopatologia ikerketa sareko ikertzaileak dira.
The post Probiotikoen erabilgarritasuna obesitatearen tratamendurako appeared first on Zientzia Kaiera.
Dos casos sorprendentes de dispersión vegetal a través del tracto digestivo animal
Los animales colaboramos activamente en la dispersión de los vegetales. Este fenómeno se denomina zoocoria. En muchos casos, la relación es mutualista e implica beneficios para ambas partes. Las plantas amplían su área de distribución y disminuyen la competencia entre ellas. A cambio, los animales recibimos recompensas en forma de frutos comestibles. Cuando las semillas pasan a través del tracto digestivo de los animales y son devueltas al medio ambiente por defecación o regurgitación, hablamos de endozoocoria.
Muy recientemente se han publicado dos artículos que describen casos sorprendentes de endozoocoria. El primero de ellos da una vuelta de tuerca al proceso, ya que trata de semillas destinadas a la alimentación de roedores que son rescatadas de dicho destino por serpientes de cascabel (Crotalus atrox) (Figura 1). Este fenómeno se conoce como diploendozoocoria, y acaba de ser descrito por un grupo de biólogos estadounidenses.
 Figura 1. A la izquierda el palo verde (Parkinsonia microphylla) / Foto: Stan Shebs, licencia CC BY-SA 3.0. Derecha, arriba, el roedor Geomys bursarius acumula gran cantidad de semillas en sus abazones / Dominio público. Abajo, la serpiente de cascabel Crotalus atrox / Foto: Gary Stolz – dominio público.
Figura 1. A la izquierda el palo verde (Parkinsonia microphylla) / Foto: Stan Shebs, licencia CC BY-SA 3.0. Derecha, arriba, el roedor Geomys bursarius acumula gran cantidad de semillas en sus abazones / Dominio público. Abajo, la serpiente de cascabel Crotalus atrox / Foto: Gary Stolz – dominio público.El palo verde (Parkinsonia microphylla) (Figura 1) es un arbusto de los desiertos del oeste de Norteamérica. Sus semillas caen al suelo en mayo-junio y germinan aprovechando las ocasionales lluvias del verano. Muchos roedores, por ejemplo Geomys (Figura 1), se alimentan de estas semillas, almacenándolas en sus abazones (bolsas en las mejillas). Ahí es donde intervienen las serpientes de cascabel, depredadoras de roedores. Cuando la presa es devorada y digerida, las semillas son expulsadas en 5-7 días con los excrementos. La pregunta era si estas semillas siguen siendo viables tras tantos avatares.
El estudio citado consistió en alimentar serpientes con ratones de laboratorio descongelados. En estos ratones se habían introducido semillas de palo verde, que fueron recuperadas con los excrementos. Las semillas se sembraron en condiciones naturales y se compararon con semillas recogidas directamente del suelo. Un 28% de estas últimas germinaron, y ese porcentaje fue prácticamente idéntico al de las semillas expulsadas por las serpientes. Es más, cuando las semillas se sembraron junto con los excrementos de las serpientes (que incluyen uratos de la orina), el porcentaje de éxito subió al 40%. Es decir, las serpientes no solo rescataron las semillas de su destino alimenticio, sino que probablemente mejoraron su viabilidad al abonarlas.
El otro caso de endozoocoria no es menos insólito, aunque no implica semillas. Se trata de una especie de ñame (Dioscorea melanophyma), una planta con raíces tuberosas de zonas montañosas y subtropicales de China y otros países asiáticos. Estos ñames han perdido su capacidad para reproducirse sexualmente, y se multiplican mediante bulbillos o propágulos clonales, conjuntos de células con capacidad de generar un nuevo individuo. Esto no es raro entre las plantas. La reproducción asexual, aunque renuncie a la recombinación genética, permite prescindir del requerimiento de una pareja y de mecanismos de polinización. El inconveniente es que las plantas que se reproducen por propágulos clonales están muy limitadas en su capacidad de dispersión.
 Figura 2. Los bulbillos del ñame Dioscorea melanophyma (A) son idénticos a las bayas de Cipadessa baccifera (B). A la derecha y arriba, el rango de tamaños de los bulbillos del ñame (banda rosa) se solapa con el tamaño de la mayor parte de bayas de las plantas que pueblan su área geográfica (barras verticales). Abajo, la reflectancia en el espectro luminoso entre 300 y 700 nm (ultravioleta – rojo lejano) de los bulbillos (líneas rojas) se solapa con la reflectancia de las bayas. El inserto muestra el mismo solapamiento cuando los datos se representan mediante escalamiento multidimensional no métrico. Esto indica que el color de bulbillos y bayas percibido por las aves es el mismo. Fuente: Chen et al. (2026), cita completa en referencias, licencia CC BY-NC-ND 4.0.
Figura 2. Los bulbillos del ñame Dioscorea melanophyma (A) son idénticos a las bayas de Cipadessa baccifera (B). A la derecha y arriba, el rango de tamaños de los bulbillos del ñame (banda rosa) se solapa con el tamaño de la mayor parte de bayas de las plantas que pueblan su área geográfica (barras verticales). Abajo, la reflectancia en el espectro luminoso entre 300 y 700 nm (ultravioleta – rojo lejano) de los bulbillos (líneas rojas) se solapa con la reflectancia de las bayas. El inserto muestra el mismo solapamiento cuando los datos se representan mediante escalamiento multidimensional no métrico. Esto indica que el color de bulbillos y bayas percibido por las aves es el mismo. Fuente: Chen et al. (2026), cita completa en referencias, licencia CC BY-NC-ND 4.0.La estrategia de Dioscorea melanophyma para dispersarse consiste en dar a sus bulbillos la forma y el color de las bayas de otras plantas con flores y frutos que comparten su área geográfica (Figura 2). Un estudio de investigadores chinos ha demostrado que esta semejanza es absoluta. Hasta 22 especies de aves confunden los bulbillos del ñame con las bayas que constituyen su alimentación. Eso sí, tras un corto tránsito intestinal (alrededor de media hora) los bulbillos salen con las deposiciones sin haber sido digeridos, y mantienen toda su capacidad germinativa. Se pudo comprobar que un 86,5% de los bulbillos germinan tras haber sido defecados por las aves, frente a un 92% de los recogidos directamente de los ñames. La diferencia no fue estadísticamente significativa. Por otro lado, se comprobó que la dispersión de los bulbillos por parte de las aves fue de 230 metros de media. Un 6% de los bulbillos cayeron a más de 500 metros de la planta madre. Estos valores igualan a los que obtienen las plantas con auténticas bayas que deben recompensar a los pájaros para lograr esa dispersión.
Se trata de un asombroso caso que nos recuerda al mimetismo batesiano, en el que una especie adopta el aspecto de otra que es tóxica o peligrosa, para evitar ser depredada. Pero en este caso es justo al revés, una especie de planta adopta en sus propágulos indigeribles el aspecto de frutos comestibles precisamente para que sean devorados. La Naturaleza no deja de sorprendernos.
Referencias
Acevedo, M., Salywon, A.M., Blackwell, S.A. et al. (2026). The potential for seed rescue and secondary dispersal in rattlesnakes. R Soc Open Sci. doi: 10.1098/rsos.251226
Chen, Z., Chomicki, G., Li, Y. et al. (2026). Berry Batesian mimicry enables bird dispersal of asexual bulbils in a yam. Proc Natl Acad Sci U S A. doi: 10.1073/pnas.2528094123
Sobre el autor: Ramón Muñoz-Chápuli Oriol es Catedrático de Biología Animal (jubilado) de la Universidad de Málaga.
El artículo Dos casos sorprendentes de dispersión vegetal a través del tracto digestivo animal se ha escrito en Cuaderno de Cultura Científica.
Iberiar otsoen dieta gorozkietan dagoen DNA bidez berreraikia
Euskal Herriko Unibertsitateko (EHU) eta Madrilgo Unibertsitate Autonomoko (UAM) ikerketa-taldeek, Sendaviva natura parkearekin elkarlanean, gorotzen azterketa genetikoak otsoen dieta zehaztasun osoz, harrapatu beharrik izan gabe, berreraikitzea ahalbidetzen duela frogatu dute.
Iberiar otsoek (Canis lupus signatus) aztarna ikusezinak uzten dituzte gorozkietan. DNAren zatiek zer espezie eta zer proportziotan kontsumitzen duten identifikatzeko aukera eskaintzen die zientzialariei. Lana Scientific Reports aldizkarian argitaratu dute eta ‘DNA metabarcoding’ izeneko teknikak harrapakari handien elikadurari (haien kontserbaziorako funtsezko alderdia da) buruzko azterlan zehatzagoak egiteko aukera zabaltzen du.
 Irudia: harrapakari handien kontserbaziorako funtsezko alderdia da eta, ‘DNA metabarcoding’ izeneko teknikak haien elikadurari buruzko azterlan zehatzagoak egiteko aukera zabaltzen du. (Argazkia: Natalia García Prieto – Pexels lizentziapean. Iturria: Pexels.com)
Irudia: harrapakari handien kontserbaziorako funtsezko alderdia da eta, ‘DNA metabarcoding’ izeneko teknikak haien elikadurari buruzko azterlan zehatzagoak egiteko aukera zabaltzen du. (Argazkia: Natalia García Prieto – Pexels lizentziapean. Iturria: Pexels.com)Teknika horretan, lagin batean dauden DNA zatiak (kasu honetan gorozkiak) atera eta modu masiboan sekuentziatzen dira, gero datu baseekin alderatzeko, zati horiek zer espezierenak diren identifikatzeko. Espezie bakoitzak “barra kode” berezi bat du, eta, horri esker, identifikatu egin daitezke, baita ilearen, hezurren edo lumaren arrastorik geratzen ez denean ere.
Tradizioz, haragijaleen dieta aztertzeko, gorozkietan edo urdailetan zeuden hondar fisikoak (ileak, hezurrak, lumak) behatu ohi ziren, baina prozedura neketsua eta mugatua zen. “Teknika honi esker, gorozkien lagin bati esker, otsoak azken egunetan zer jan duen jakin dezakegu”, azaldu du Jabi Zabalak, EHUko ikertzaile eta lanaren egile nagusiak.
Nafarroan egindako kontrolatutako esperimentuaMetodoa fidagarria den egiaztatzeko (aldez aurreko azterketak ingurune naturalean jasotako gorozkietan oinarritzen zirenez, ez zen izaten irentsitakoari edo proportzioei buruzko informaziorik izaten), taldeak esperimentua diseinatu zuen Sendaviva (Nafarroa) natura parkean. 42 egunez, otsoak sei dieta ezberdinekin elikatu zituzten, proportzio ezberdinetan. Dietak bederatzi ornodun espezieren nahasketa ezagunez osatuta zeuden (oreinak, basurdeak, oilaskoak edo untxiak).
Guztira, 50 gorozki lagin jaso eta laborategian aztertu zituzten. “Horrez gain, ‘primer’ blokeatzaileen erabilera ere probatu genuen. DNAren sekuentzia txikiak dira, eta otsoaren material genetikoak (oso ugaria izaten da gorozkietan) bere harrapakinena ezkutatzea eragozten du”, zehaztu du Xabier Cabodevillak, ikerlanaren egileak.
Analisiek erakutsi zutenez, sekuentzia genetikoen ugaritasun erlatiboak modu leialean islatzen zuen dieta esperimentalen benetako konposizioa. Blokeatzailerik gabe, ereduak dietaren aldakuntzaren % 81,5 frogatu zuen, aurreko lanen emaitzak gaindituz. Blokeatzaileak handitu egin zuen harrapakin irakurketen ehunekoa (% 5,6tik % 34,5era), nahiz eta zehaztasuna pixka bat murriztu eta okerreko detekzio gehiago (“positibo faltsuak”) sartu. Azterketak, gainera, agerian utzi zuen gorozkien lagin bakoitzak azken 1,5 eta 1,8 egun arteko tarteko dieta islatzen duela eta horrek azterketaren denbora mailako esparrua mugatzea ahalbidetzen du.
Kontserbaziorako funtsezko tresnaHorrenbestez, emaitzek agerian utzi dute ‘DNA metabarcoding’ teknika haragijale handien dieta aztertzeko teknika fidagarria eta kuantitatiboa dela. Ugariak dira bere aplikazioak:
- Kontserbazioa eta kudeaketa: harrapakin naturalen eskuragarritasuna ebaluatzen eta abeltzaintzarekin gertatu ohi diren gatazkak gutxitzen laguntzen du.
- Ekologia trofikoa: elikadura sareak berreraikitzen eta harrapakariek ekosistemetan betetzen duten rola ulertzen laguntzen du.
- Espezie mehatxatuen jarraipena: behatzeko zailak diren animalien (hartzak, katamotzak edo felido handiak, adibidez) kasuan azterlanak egitea errazten du.
“Ikerketa honek erakusten du teknikak otsoen benetako dietari buruz aurrekaririk gabeko ezagutza eskaintzen duela. Iberiar penintsulan horien kontserbazioa kudeatzeko eta, aldi berean, abeltzaintza estentsiboan izaten dituen inpaktuak zehaztasun handiagoz ebaluatzeko eta baterako existentziarako estrategia eraginkorragoak diseinatzeko ezinbesteko aurrerapena da”, adierazi du Pablo Acebesek, UAMeko ikertzaile eta lanaren egileak.
Iturria:EHU prentsa bulegoa: “Gorozkietan ezkutuan dagoen DNAk zehaztasun osoz erakusten du iberiar otsoen dieta“.
Erreferentzia bibliografikoa:Zabala, Jabi; Acebes, Pablo; Madeira, María J.; Fernández, Efrén; Gómez-Moliner, Benjamín Juan; Cabodevilla, Xabier (2025). Metabarcoding provides accurate estimation of volumetric diet composition in a top predator despite interference from blocking primers. Scientific Reports, 15, 29033. DOI: 10.1038/s41598-025-14837-9
The post Iberiar otsoen dieta gorozkietan dagoen DNA bidez berreraikia appeared first on Zientzia Kaiera.
La amenaza cuántica: hay que prepararse para el ‘Día Q’
En algún momento del futuro –no sabemos si dentro de décadas o antes de lo esperado– podría llegar el llamado ‘Día Q’ (Q-Day): el día en que un ordenador cuántico lo bastante potente sea capaz de romper la criptografía que hoy protege prácticamente toda nuestra vida digital.
Para entender la magnitud del problema, basta imaginar que, de repente, todas las cerraduras digitales dejan de funcionar: la banca online, el correo electrónico, las aplicaciones de mensajería, los sistemas de los gobiernos o el comercio electrónico quedarían expuestos. Nada estaría protegido. Nada.
 Foto de FlyD en UnsplashQué es lo amenazado
Foto de FlyD en UnsplashQué es lo amenazado
La amenaza cuántica no afecta a los datos en sí, sino a las matemáticas que usamos para protegerlos. Cada vez que enviamos un mensaje por WhatsApp, accedemos a nuestra cuenta bancaria o compramos algo por internet, el texto legible (“texto en claro”) se transforma en un galimatías incomprensible (“texto cifrado”). Solo quien tiene la clave adecuada puede revertir el proceso. Es una versión moderna del trabajo de los espías de antaño, pero automatizada y basada en algoritmos matemáticos.
Los principios que hacen que estos sistemas sean seguros se establecieron ya a mediados del siglo XX, por ejemplo en los trabajos de la obra seminal de Claude Shannon sobre el secreto perfecto.
La criptografía: tipos y seguridadExisten dos grandes tipos de criptografía. En la criptografía simétrica, emisor y receptor comparten una misma clave, como si ambos tuvieran una copia idéntica de la llave de una caja fuerte. El problema es evidente: ¿cómo se entrega esa llave sin que nadie más la copie? Aquí entra en juego la criptografía asimétrica o de clave pública, que usa un par de claves: una pública (que se puede compartir) y otra privada (que se guarda en secreto).
Algoritmos como Diffie-Hellman permiten que dos personas acuerden una clave secreta aunque estén hablando por un canal público, apoyándose en problemas matemáticos muy difíciles de resolver para los ordenadores actuales, como el logaritmo discreto.
Otro sistema para intercambiar claves secretas y cifrar mensajes, RSA, basa su seguridad en la dificultad de descomponer números enormes en sus factores primos, algo trivial para números pequeños pero casi imposible para los grandes.
Gracias a estas técnicas, además de cifrar, podemos firmar digitalmente documentos, del mismo modo que una firma manuscrita identifica al autor, pero con garantías matemáticas. Para saber quién hay detrás de una clave pública se usan los certificados digitales, emitidos por autoridades de confianza, algo parecido a un DNI digital.
Primeras grietas en la criptografía de clave públicaDurante años, estos sistemas han sufrido mejoras y correcciones, pero su base teórica parecía sólida… hasta que apareció el algoritmo de Shor. En 1997, el matemático estadounidense Peter Shor demostró que un ordenador cuántico suficientemente potente podría resolver con facilidad los problemas matemáticos en los que se basan Diffie-Hellman y RSA. Dicho de otro modo: las cerraduras actuales están diseñadas para ladrones clásicos, no para ladrones cuánticos.
Si ese ordenador existiera hoy, las comunicaciones bancarias y las que involucran secretos empresariales o datos gubernamentales podrían ser descifradas. Ese sería el temido Día Q.
¿Qué pasa tras Shor?Del mismo modo que el ordenador cuántico presenta problemas, también depara soluciones. Así, es posible aprovechar propiedades de la mecánica cuántica, como el principio de no clonación de estados cuánticos, para establecer protocolos de distribución cuántica de claves (QKD, por sus siglas en inglés) simétricas. También es factible aprovechar la capacidad de cómputo paralelo derivada de propiedades como la superposición de estados cuánticos.
Por otro lado, la denominada criptografía post-cuántica haría viable implementar criptografía de clave pública mediante problemas matemáticos que son de elevada complejidad para los ordenadores actuales. Entre tales problemas se encontraría el aprendizaje con errores o LWE (Learning With Errors), teoría de códigos, resolución de sistemas de ecuaciones no lineales en varias variables sobre cuerpos finitos, la inversión de funciones hash, etc.
No basta con remplazar un algoritmo por otroNo basta con sustituir una pieza. Cambiar la criptografía implica actualizar protocolos de comunicación (como los que protegen las webs seguras), aplicaciones (correo cifrado, mensajería instantánea) y también dispositivos físicos: routers, servidores, tarjetas inteligentes o sistemas industriales antiguos que no se pueden renovar fácilmente. Es como cambiar todas las cerraduras de una ciudad sin detener su actividad diaria.
Por eso, organismos como la Comisión Europea o el NIST en Estados Unidos están definiendo hojas de ruta y estándares para una transición gradual y flexible. La posibilidad de estar a merced de una ventaja estratégica por parte de actores o países externos ha hecho que a nivel europeo se esté promoviendo el desarrollo de tecnología y de procedimientos para empezar a desplegar criptografía resistente a ataques cuánticos.
También asegurar las máquinasY no solo hay que preparar los productos software: también hay que adaptar los dispositivos hardware de comunicaciones, almacenamiento y cómputo de información. El reto es aún mayor en sectores industriales con maquinaria, sistemas y productos antiguos (legacy), donde una actualización puede ser costosa o arriesgada. Además, los cambios en seguridad suelen tener efectos inesperados, lo que hace que muchas organizaciones retrasen decisiones críticas, aun sabiendo que el riesgo crece con el tiempo.
En general, los sectores productivos tienen cierta inercia frente a cambios de consecuencias no anticipables. Los cambios en arquitectura y productos de seguridad, sobre todo en lo relativo a la criptografía, suelen tener consecuencias no esperadas, y esto hace que se paralicen cambios necesarios.
Autonomía estratégica y capitalización del talentoNo sabemos cuándo llegará realmente el ordenador cuántico capaz de romper la criptografía actual, pero esperar sin prepararse no es una opción. Mientras ello ocurre es preciso invertir de forma adecuada tiempo y recursos para desarrollar competencias criptográficas y de desarrollo de hardware que nos permitan estar preparados frente a la irrupción de amenazas asociadas a la nueva computación.
La seguridad de un país o de una región depende de contar con talento, recursos y capacidad tecnológica propia. En el caso europeo, la fuerte dependencia de terceros en hardware y software de seguridad hace que invertir en conocimiento y autonomía estratégica sea clave para afrontar, con garantías, la llegada del Día Q.![]()
Sobre el autor: David Arroyo Guardeño, Científico Titular. Ciberseguridad y protección de la Privacidad. Instituto de Tecnologías Físicas y de la Información «Leonardo Torres Quevedo» (ITEFI).
Este artículo fue publicado originalmente en The Conversation. Artículo original.
El artículo La amenaza cuántica: hay que prepararse para el ‘Día Q’ se ha escrito en Cuaderno de Cultura Científica.
Alejandra Melfo: «Ezagutza sendoaren bitartez lagundu nahiko nuke, aurrerago beste pertsona batzuek ezagutza horretatik abiatuta eraiki ahal izateko»
Alejandra Melfo Fisikan lizentziatu zen Andeetako Unibertsitatean (Venezuela) eta Astrofisikan doktorea da (SISSA, Italia). Gaur egun irakaslea da Andeetako Unibertsitatean. Bere karreraren zatirik handiena energia handiko fisika ikertzen eman du, bereziki bateratze handiko teoriei eta akats topologikoei lotuta.
Berriki, glaziarren ikerketa eta kontserbazioa izan ditu aztergai, zehazki Pico Humboldt mendian dagoen La Corona glaziarrarena; izan ere, Venezuelako azken glaziar tropikala da, eta klima aldaketaren eta berotze globalaren ondorioz arriskuan dago. Halaber, zeregin aktiboa izan du bere herrialdean, ingurumen sentsibilizazioaren eta heziketaren esparruan.
Alejandra Melfo eta Jorge Drexlerrek Despedir a los glaciares abestia egin zuten (Salvavidas de hielo albuma, 2017), glaziarrak desagertzearen eta horrek eragindako ondorioen inguruko kezka aditzera emateko.

Ia 30 urte eman nituen fisika teorikoaren arloan, bereziki energia handiko fisikaren arloan, edo, bestela esanda, oinarrizko partikulekin lanean. Duela hamar urte ibilbidea aldatu nahi nuen eta biologian murgildu naiz, eremu glaziarren ekologiari eta mikrobiologiari lotutako zenbait proiektutan, eta, zehazki, Venezuelako azken glaziarren desagerpenari lotuta, bertan bizi bainaiz.
Zergatik aritzen zara arlo horretan?Aukera bat izango litzateke esatea ezagutza areagotzea eta zientziaren arloko galderei erantzutea gustuko dudala, edo, berriki, ingurumena kontserbatzeko premia dibulgatzea gustuko dudala, baina ez da egia. Izan ere, ikerketa munduko gauzarik dibertigarriena da, bizitza adierazgarri egiten duen lana baita. Nire herrialdeko egoeraren ondorioz (krisia eta unibertsitateen kolapsoa) beste arlo batzuetan lan egin behar izan dut, hala nola dibulgazio zientifikoaren esparruan, baina denbora gehiago eman nahiko nuke ikertzen.
Izan al duzu erreferentziazko figurarik zure ibilbidean?Ez nuke halakorik esango. Zientzialari ezagunak beti erreferentetzat hartzen ditugu, baina baita hain ospetsuak ez direnak ere. Zientzia egitean gehien gustatzen zaidan gauzetako bat da errealitatean lana taldean egin behar dela, bestek ikertzaile batzuekin lankidetzan aritzen garelako, edo, ezagutzen ez ditugun arren, haien lana jarraitu eta haiek egindakoaren gainean eraikitzen dugulako. Beti dago lanbidea erakusten digun tutore bat, eta hori da gure abiapuntua, baina esan nahiko nuke taldea dela erreferentziazko benetako figura, taldekako lana baita.
Zer aurkitu edo konpondu nahiko zenuke zure arloan?Bada, beti buruan galdera esanguratsuak dauzkagu; adibidez, partikulen fisikaren arloan lan egiten nuenean neure buruari zera galdetzen nion: «existitzen al dira monopolo magnetikoak?» edo «zein da bateratze handiaren eskala, indar guztiak indar bera osatzen dutenean? eta hori gertatu al zen unibertsoa gaztea zenean?». Gaur gaurkoz, honako hau izango litzateke: «zer nolatan dago bizi forma bakarra gure planetan, denok erabiltzen dugun molekula berarekin (bakterioetatik hasi eta elefanteetaraino)?». Baina, errealitatean, erantzun ditzakegun galdera txikietan zentratzen gara, edo, behintzat nik beti horrela ikusi izan dut. Hortaz, anbizio txikiagoko galderak egiten dizkiogu gure buruari, hala nola: «zer gertatuko da izotzean bizi diren bakterioekin glaziarra urtzen denean? Ekosistema berriaren parte izango dira?». Eta horrela eraikitzen goaz. Ezagutza sendoarekin lagundu nahiko nuke, aurrerago beste pertsona batzuek ezagutza horretatik abiatuta eraiki ahal izateko.
Zer aholku emango zenioke ikerketaren munduan hasi nahi duen norbaiti?Egin dezala. Izugarri disfrutatuko du. Bestela, bizitza erdia eman dezake gauza bat egiten, eta aurrerago beste toki batean hutsetik hasi; beraz, aurrera, beldurrik gabe.
Jatorrizko elkarrizketa Mujeres con Ciencia blogean argitaratu zen 2025eko azaroaren 8an: “Alejandra Melfo: «Me gustaría contribuir con conocimiento sólido, desde el que otras personas puedan construir más adelante».
Itzulpena: EHUko Euskara Zerbitzua
Ikertzen dut atalak emakume ikertzaileen jardunari erreparatzen die. Elkarrizketa labur baten bidez, zientzialariek azaltzen dute ikergai zehatz bat hautatzeko arrazoia zein izan den eta baita ere lanaren helburua.
The post Alejandra Melfo: «Ezagutza sendoaren bitartez lagundu nahiko nuke, aurrerago beste pertsona batzuek ezagutza horretatik abiatuta eraiki ahal izateko» appeared first on Zientzia Kaiera.
Naukas Bilbao 2025: El misterio de la momia maldita

Acompaña a Gemma Marfany en una aventura fascinante de genética forense para desentrañar los misterios que rodean a una momia egipcia de hace 3200 años como ninguna otra: la momia que grita.
Gemma Marfany Nadal es catedrátrica de Genética de la Universitat de Barcelona. Posee una larga trayectoria como Investigadora Principal de un grupo de investigación de genética molecular humana centrado en el diagnóstico genético de enfermedades hereditarias.
Edición realizada por César Tomé López
El artículo Naukas Bilbao 2025: El misterio de la momia maldita se ha escrito en Cuaderno de Cultura Científica.

